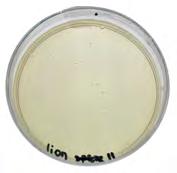
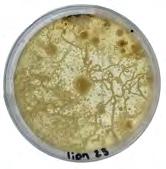
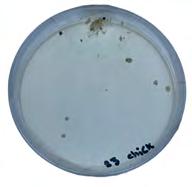

FOREST IN THE MACHINE
COMPUTATIONAL DESIGN FROM ORGANIC ORIGINS
BY AITCH M HUNT

ACKNOWLEDGMENT
I extend my deepest gratitude to everyone who has contributed to the completion of this course. Over the past two years, I have grown and evolved immensely thanks to the incredible community of mentors, peers, inspiring researchers, and administrators at Bio-integrated Design. Special thanks to the visionaries behind this remarkable program, Marcos Cruz and Brenda Parker. Your belief in us and your dedication to fostering a rich environment for learning and connection have been truly invaluable.
I am profoundly grateful to our tutors, who have been steadfast supports in times of stress, insightful mentors during constructive critiques, and cherished friends in moments of shared success. Your guidance and encouragement have been vital. Tony, your unwavering dedication and exceptional assistance with our computational needs have been nothing short of amazing. Thank you for your relentless hard work, care, and interest in helping students navigate even the wildest of computational challenges.
My heartfelt thanks also go to the staff at Here East for their patience with our late-night sessions, their assistance with equipment, and their maintenance of a clean and productive workspace. The B-made staff deserve a special mention for enabling us to create projects beyond our imagination, always prioritizing student success and offering invaluable advice and support.
I am deeply appreciative of the researchers who have inspired me and others along the way. A special thank you to Lorenzo for allowing us to explore his beautiful land in Chianti, Italy, and for his holistic approach to drystone architecture. Your guidance has helped us achieve new heights of beauty and understanding. Thanks also to Oz, Ashley Beckwith, Lukas Allner, Andreas (the creator of Wasp for Grasshopper), and Seda Zirek for the enlightening conversations and their help in advancing our ideas and industry knowledge.
Lastly, I want to express my profound gratitude to my fellow students. It has been an honor and a pleasure to work with such an extraordinary cohort. I am excited to see what the future holds for these incredible individuals.
I could not have completed this course to the extent I have without the support and inspiration of everyone involved in and adjacent to Bio-ID. Thank you all for being part of this transformative journey.

ABSTRACT
This almanac represents the culmination of two years of intensive study and research in Bio-Integrated Design, exploring the intersection of natural materials, computational design, and robotic fabrication for sustainable construction. The project investigates the integration of unprocessed natural materials such as stone and tree branches with advanced computational techniques to create large-scale, ecologically beneficial structures.
Central to this research is the development of algorithms that translate the irregular geometries and behaviors of organic materials into computable data, enabling precise robotic fabrication. This approach not only aims to achieve architectural stability but also focuses on optimizing the ecological benefits of structures, such as enhancing biodiversity and promoting sustainable ecosystems.
A significant component of this research involves hierarchical material studies, which examine the layered organization of natural materials and their potential applications in modern design. These studies draw parallels with cell bioprinting materials, highlighting how understanding the hierarchical complexity of biological tissues can inform the development of materials and structures that are both functional and integrated with natural systems. By mimicking the natural growth patterns of tissues, this research aims to create materials that can be used in bioprinting and other advanced manufacturing processes.
One key project documented in this almanac involves the use of living, dead, and decaying wood to construct adaptive architecture for temporary outdoor structurs. By leveraging computational simulations and robotic fabrication techniques, the project ensures logical assembly and predicts the growth and decay patterns of wood, resulting in a structure that supports itself and integrates seamlessly with its natural surroundings.
Automation plays a critical role in this research, operating at various levels of integration with nature. From the precise control of robotic fabrication to the adaptive algorithms that respond to environmental conditions, automation enhances the ability to create structures that are both resilient and environmentally harmonious. This approach extends to natural bioremediation methods, where the design and deployment of materials can actively contribute to cleaning and revitalizing ecosystems.
The almanac also delves into the hierarchical complexity of natural forms, exemplified by studies on micro-structures and symbiotic complexes. These studies illustrate how understanding and mimicking natural processes can lead to innovative design solutions that are both functional and environmentally harmonious.
Acknowledging the invaluable contributions of mentors, peers, and researchers, this work reflects a collaborative effort to push the boundaries of sustainable design. By translating ancient heuristics into modern logistical frameworks, the project aspires to foster a symbiotic relationship between human construction and the natural world, paving the way for a future where built environments not only coexist with but actively benefit the ecosystems they inhabit.
This body of work demonstrates the potential of bio-integrated design to create resilient, adaptive structures that embody a continuous cycle of life, death, and rebirth, ultimately contributing to a more sustainable and harmonious way of living.
INTRODUCTION
The journey through the Bio-integrated Design course has focused on the intersection of natural materials, computational design, and advanced fabrication technologies. Central to the research is the development of computational logic that translates the form and behavior of organic materials into a language compatible with advanced fabrication robotics, known as biohybrid robotics.
A key theme has been the hierarchical study of natural structures. By analyzing the layered complexity of biological forms, principles were derived to inform innovative architectural and material solutions. This approach provided critical insights into the structural organization of biological tissues, guiding the development of advanced materials and methods for modern engineering and design.
Automation at various levels has been a focal point. Initially concentrated on robotic fabrication to manipulate natural materials, the research expanded to include adaptive algorithms and computational simulations responsive to environmental conditions. This evolution highlights a sophisticated understanding of how technology can synergize with natural processes to create resilient, adaptive designs.
Bioremediation through design also emerged as a significant interest. The goal was to redefine architectural efficiency by developing materials and structures that actively contribute to environmental health. This approach emphasizes creating built environments that positively interact with and support natural ecosystems.
Workflows evolved from conceptual sketches and material experiments to sophisticated computational models and robotic fabrication techniques. Early research into vernacular construction methods and natural growth patterns informed the development of algorithms optimizing the use of irregular, organic materials. The integration of 3D scanning, digital cataloging, and robotic automation enabled precise assembly, leading to innovative and functional design solutions.
MICROSTRUCTURES
CLAY PRINTING
LICHEN STUDIES
BIOPRINTING

Themes of harmonizing with nature, leveraging technological advancements, and fostering ecological sustainability have guided this work. This portfolio demonstrates the potential of bio-integrated design to create structures that meet human needs while enhancing the natural world. By developing computational logic that bridges organic material and advanced robotics, a future is envisioned where biohybrid robotics leads to more sustainable and interconnected living environments.

1
WETLANDS ECOSYSTEM
WILLOW SPILING
FLOODING & EROSION

COMPUTER SIMULATIONS
INTERVENTIONS
AUTONOMOUS SYSTEMS
EVOLUTIONARY ALGORITHMS
3D SCANNING WORKFLOW
BIOINFORMATICS
DRYSTONE ECOLOGY
AGGREGATION LOGIC

ROBOTIC MILLING
TREE SHAPING & GRAFTING
PROGRAMMABLE DECAY
WOODEN JOINTS
TREE BIOLOGY
BRANCH AGGREGATION
NON-STANDARD OPTIMIZATION
STABILITY ANALYSIS
ENVIRONMENTAL ANALYSIS YEAR 2

01.
MICRO-MOTIFS
CONCEPT MODELING ANALYSIS FABRICATION CASE STUDY APPLICATION
02.
INTERSTITIAL FLOWS
VISION PRECEDENTS FORM-FINDING ECOLOGICAL RELATIONSHIPS SIMULATION RENDERINGS
03. 04. RAG_ODI
OVERVIEW DESIGN BIOINFORMATICS MATERIAL AGGREGATION LOGIC FABRICATION
LIFE & DECAY
INTRO STATE-OF-THE-ART THE LIVING THE DECAY THE DEAD THE MAKING RESEARCH & EVOLUTION INTEGRATION


MICRO-MOTIFS
THE BREAKDOWN OF COMPLEX TISSUES INTO MODULAR COMPONENTS
High-functioning materials are often composed of an arrangement of modular structures on a surface at various hierarchical scales. These seemingly complex architectures have many useful functions such as hydrophobicity, adhesion, and self-cleaning abilities. In this study, the modular motif that composes different functional materials will be isolated and re-applied to various surfaces and compositions of hierarchy. Through this exploration, new perspectives in designing functional materials will be acquired.
HIERARCHY OVERVIEW
This section explores the fundamental building blocks of organic tissues: the three-dimensional cellular units. These motifs serve as the primary structural elements, each with unique properties and functions.
Here, we examine how these 3D cellular motifs arrange themselves into patterns on a surface, forming tissues. The spatial organization and interactions of motifs within these patterns are critical for the overall behavior and functionality of the tissues.
Finally, we utilize computational simulations to analyze and predict the functionality of these hierarchical arrangements. This section focuses on modeling the dynamic interactions and potential applications of these complex biological structures.
This section delves into the next level of complexity, where patterned tissues are organized into larger, dynamic structures. These architectures, akin to organs, exhibit emergent properties and behaviors arising from the collective interaction of tissues.

MODELING MOTIFS
POLLEN GRAINS

Halbritter, Heidemarie & Silvia, Ulrich & Grímsson, Friðgeir & Weber, Martina & Zetter, Reinhard & Hesse, Michael & Buchner, Ralf & Svojtka, Matthias & Frosch-Radivo, Andrea. (2018). Palynology: History and Systematic Aspects. 10.1007/978-3-319-71365-6_1.


Procedural modeling of pollen grains using platonic solids and negative spaces. This 3D study explored the various morphologies in which the pollen grain has evolved over time and throughout various environmental conditions. Each newly emerged form represents an adaption that has in some way promoted the safe transport of these singlecelled grains to their final destination for further reproduction.
MODELING THE MOTIF
GECKO SKIN


The adhesive pad of a gecko’s foot is made up of several levels of tiny structures. At the largest level, the gecko’s foot has special toe pads that help it stick to surfaces. These toe pads are covered with millions of tiny hairs called setae. Each seta splits into hundreds of even smaller tips called spatulae. These spatulae grip surfaces using weak forces, allowing geckos to stick to almost anything. This layered structure, from toe pads to setae to spatulae, makes gecko feet incredibly effective at clinging to surfaces. This study isolated the setae as the micromotif to be modeled.

(https://www.chemistryworld.com/news/gecko-inspired-adhesive-unsticks-witha-flash-of-light/2500275.article# ).

SETAE
MODELING THE MOTIF


The lichen complex has several layers. At the largest level, a lichen looks like a plant-like growth called a thallus, found on rocks and trees. It is a partnership between a fungus and an algae/cyanobacterium. The thallus provides structure and protection. Inside it, the fungus holds water and the algae or cyanobacterium makes food through photosynthesis. Lichens also have apothecia, small cup-shaped structures on the thallus, where the fungus produces spores. This layered organization helps lichens survive in many different environments. In this study, the apothecia has been isolated and 3D modeled.
LICHEN COMPLEX
APOTHECIA
XANTHORIA PARIENTINA
THALLUS
LICHENIZING FUNGI
EXPLORING ISOLATION & CULTIVATION TECHNIQUES



MOTIFS TO SURFACES
Various tissues types were analyzed, 3D modelled, and fabricated using isolated motifs as a starting point for procedural scattering over a dedicated surface. Interest in these surfaces was influenced by their abilities to repel or collect water from their atmosphere. These tissues include (from top to bottom) a beetle’s shell, a cactus trichome, and spider silk. The various functions exhibited by these procedural surfaces include: super/hydrophobicity, self-cleaning, anti-icing, UV protection, adhesion, antiadhesion, water collection, directionality.
The bottom diagrams shows an investigation into the hierarchical scales of the components involved in the hydrophobic properties of a spider’s web. Water beads aggregate along a single thread do to a layering of microstructures. The “capture spiral” is defined by the sum degree of rotation in which these threads come together to form, initiating a directionality of water flow towards the center of the web.








SURFACE MODELING
PITCHER PLANT
Conversion to threshold values



Nano-Micro Lett. (2017) 9:23

SEM microscopy

coversion
The interior surface of the pitcher plant, Nepenthes alata, has a unique microstructure has evolved to be nearly impossible for an insect foot to attatch to as it plumets can be converted into a 3D model of this unique surface.
Nepenthes alata

to threshold values

microstructure that enables the plant to trap and consume flies from its environment. The texture inside the pitcher plant to its death. The above image shows the process of converting an SEM image into threshold values which
3D model of surface microstructures
CLAY PRINTING
HYBRID COMPOSITE SURFACES

APOTHECIA



gecko setae
Nepenthes alata

MODELING MICROSTRUCTURES
PLANT VASCULATURE






CAMPBELL, NEIL (2002). BIOLOGY. SAN FRANCISCO, CA: PEARSON EDUCATION, INC. PP. 759. ISBN9780-8053-6624-2.


Houdini node network
2D surfaces merged into 3D model conversion network

Extracted 2D surface geo


2D surfaces merged into 3D tissue complex
CASE STUDY: EPICUTICULAR WAXES

In this investigation inspired by the paper “Plant surfaces with cuticular folds are slippery for beetles,” I explore the biomechanics of this phenomenon using advanced 3D modeling techniques. By leveraging SEM scans, I reconstruct plant surface textures in Houdini and analyze their curvature to replicate and validate the slipperiness experienced by beetles.

Nano-Micro Lett. (2017) 9:23
Figure 1 A cross-section of a plant epidermal cell, its waxy cuticle, and composing layers.

Figure 2 How a surface gets wet. γLA, γLS, and γSA are forces between liquid, solid, and air. These forces determine the water droplet’s angle. Hysteresis shows how well the droplet sticks to a tilted surface and is measured by the tilting angle or droplet angles.

HIERARCHICAL BREAKDOWN OF PLANT CUTICLES & RELATED FUNCTIONALITY


Nano-Micro Lett. (2017) 9:23

Figure 4 Depicts the various degrees of functionality a plant surfacee can exhibit based on hierarchical organication of cuticular motifs. These surface properties are as follows (left to right): hydrophillic, hydrophobic, syperhydrophobic, and superhydrophillic.
Figure 3 SEM micrographs depicting different hierarchies of cuticular folds in plant surfaces.

RESEARCH QUESTION
3D modelled surface of beetles’ adhesive pad
ARE PLANT CUTICLES SLIPPERY FOR BEETLES?

SEM image converted to black and white through threshold values

The core research question is whether plant cuticles are inherently slippery for beetles from a computational perspective. This involves a detailed examination of microstructural interactions between beetle adhesive pads and plant surfaces. Through rigorous curvature analysis, I aim to identify geometric properties that contribute to reduced friction. This study not only provides deeper insights into plant morphology and ecological interactions but also bridges the gap between biological observations and computational simulations, offering a novel perspective on biological surface dynamics.
Contact area of beetle’s adhesive pad Nano-Micro Lett. (2017) 9:23


Contact area of a beetle’s adhesive pad
Contact area of beetle’s adhesive pad

Contact area of beetle’s adhesive pad
3D modelled surface of beetles’ adhesive pad
3D modelled surface of beetles’ adhesive pad

Nano-Micro Lett. (2017) 9:23
3D modeled surface of a bettle’s adhesive pad

SEM image converted to black and white through threshold values
SEM image converted and white threshold

SEM image converted to threshold values


Nano-Micro Lett. (2017) 9:23







SEM image of various plant surfaces demonstrating differnt degrees of hierarchical folding. These images have been converted to threshold values.




3D modeled plant surfaces of varying hierarchical folding


SURFACE ANALYSIS
ADHESION
“SLIPPERINESS” OF VARIOUS SPECIES

The above image shows the 3D modeled surfaces of a beetle’s adhesive pad and its intersection with varoius degrees of epicuticular folds in which are hypothesized to directly impact the gripping aility of the insect on the plant.



analysis showing the imprint of the adhesive pad onto of the leaf surface and the resulting surface area at the interestion
Figure 1: 3D
Figure 1: 3D modeled textured surface of beetle’s adhesive pad hovering above surface texture of leaf cuticle
Figure 2: Beetle’s adhesive pad placed onto surface texture of leaf cuticle
IMPRESSION SURFACE ANALYSIS
The image below shows the resulting imprint of beetle’s adhesive pad on plant surface microstructures

RESULTS
CURVATURE OF IMPRESSION
Using curvature attributes in Houdini to measure the angle and depth of surfaces and how their interactions affect adhesion through contact angle and point interception

THE RESULTING CONSENSUS....
METHOD
Adhesion is measured by digitally subtracting the 3D surface of a beetle’s adhesive pad from plant cuticle models with varying epicuticular waxes. This reveals the interaction profile between the two surfaces. Analyzing the curvature of these profiles shows how well the beetle pad conforms to the plant surface. High curvature differences indicate poor adhesion, while low differences suggest better adhesion. This method highlights the microstructural factors affecting beetle adhesion on different plant surfaces.
RESULTS

My computational results match the experimental data in the provided chart, supporting the hypothesis that plant cuticles are slippery for beetles. The chart shows that beetles have much lower traction on surfaces with complex cuticular folds and waxes compared to smooth surfaces. Similarly, my curvature analysis reveals poor adhesion on these complex surfaces, indicated by high curvature differences between the beetle pads and plant surfaces. Both the computational and experimental data confirm that intricate plant cuticles reduce beetle traction, proving these surfaces are indeed slippery for beetles.
PLANT CUTICLES ARE SLIPPERY FOR BEETLES!!!
Prüm, Bettina & Seidel, Robin & Bohn, Holger & Speck, Thomas. (2011). Plant surfaces with cuticular folds are slippery for beetles. Journal of the Royal Society, Interface / the Royal Society. 9. 127-35. 10.1098/rsif.2011.0202.
ADDITIONAL TESTS
RADIATION + CUTICLE CURVATURE ANALYSIS

highcuticularfolds
Heveabrasiliensis(abaxialleafsurface)

medium cuticular folds
Cyclamenpersicum(petalleafsurface)

medium cuticular folds
Heveabrasiliensis(adaxialleafsurface)

smoothsurfacescoveredonlywith2Dlayersorcrustsofwax Magnoliagrandiflora(adaxialleafsurface)

hierarchical surface with cuticular folds: Litchichinensis(abaxialleafsurface)

3Depicuticularwaxes: Diospyroskaki(fruitsurface)
FUTURE OUTLOOK
MICROSTRUCTURE INSIGHTS FOR 3D CELL PRINTING
The analysis of microstructures in natural materials has far-reaching implications, particularly in the field of 3D cell printing. By understanding the hierarchical complexity and the intricate organization of biological tissues, researchers can develop more advanced and efficient methods for tissue engineering. This knowledge is crucial in addressing current challenges in plant tissue culturing techniques, which often suffer from limitations in data collection and scalability, hindering their application in large-scale production and the development of highly functional plant tissue architectures.
One promising approach to overcoming these challenges is “green bioprinting,” a method investigated by Seidel et al. This technique involves embedding photosynthetic materials within 3D hydrogels for extrusion-based printing. By immobilizing and embedding these materials, green bioprinting aims to enhance cell viability, interactions, and the ability to observe plant cell geometries and behaviors more effectively. This method provides an improved alternative to traditional plant tissue engineering, potentially revolutionizing the way plant tissues are cultured and studied.
The advances in 3D bioprinting, combined with plant tissue engineering, have led to the exploration of more efficient and sustainable methods for synthetically producing co-cultured biomaterials. For these printed constructs to be successful, they must be highly tunable, oxygen-rich, and composed of complex micro-architectures. This is where the detailed analysis of natural microstructures becomes invaluable. By replicating the natural micro-architectures found in biological tissues, researchers can create more functional and sustainable bioprinted tissues.
Improving the analysis and production methods of photosynthetic materials through green bioprinting could lead to the reconstruction of functional vascular networks in plant tissues. This would significantly enhance the manufacturing of continuous and controllable biomaterials. Such advancements could enable the production of pre-vascularization tissue constructs that are biologically relevant and highly functional, paving the way for new applications in both plant and human tissue engineering.
The synthesis of research supporting green bioprinting highlights its potential to improve plant tissue culturing techniques. Enhanced production and functionality of pre-vascularization tissue constructs are essential for developing biologically relevant materials. By leveraging the insights gained from microstructure analysis, researchers can optimize the 3D printing process, ensuring that the resulting tissues are not only viable and functional but also capable of integrating seamlessly into larger biological systems.
In conclusion, the application of microstructure analysis in 3D cell printing holds significant promise for advancing tissue engineering. By understanding and mimicking the intricate architectures of natural tissues, researchers can develop more efficient, sustainable, and functional bioprinted materials. This not only addresses current limitations in plant tissue engineering but also opens up new possibilities for the future of synthetic biology and material science.





02.
INTERSTITIAL FLOWS
EMBEDDED INTERVENTIONS
The “Interstitial Flows” project aims to create a sustainable, inhabitable interface between land and water, designed to support a diverse range of organisms and mitigate the extreme conditions of flooding and drought. By leveraging bioengineered interventions, specifically live willow staking, this project addresses the environmental challenges exacerbated by global warming. Crack willow, known for its resilience and adaptability, serves as the primary material for constructing the interface, strategically placed between land and water to manage and alleviate water-related destruction.
The vision for Interstitial Flows is to mediate the harsh impacts of global climate change by establishing a dynamic, living structure that can adapt to varying water levels. This innovative approach not only helps to control flooding and drought but also promotes biodiversity by providing a habitat for various organisms. The live stakes of crack willow are integrated into the structure, which serves as a natural barrier and filtration system, drawing inspiration from the efficiency of wetland ecosystems.
Fabrication methods for this project include biodesigning with root weaving techniques, which mimic the natural processes of wetlands. These methods ensure that the structure is both functional and environmentally harmonious. Root weaving, in particular, enhances the stability and resilience of the interface, allowing it to withstand and adapt to fluctuating environmental conditions. By emulating the water-filtering capabilities of wetlands, the structure helps to maintain the balance between land and water, fostering a healthier ecosystem.
The Interstitial Flows project exemplifies how bioengineering and ecological design can converge to create solutions for contemporary environmental challenges. By employing live willow staking and wetland-inspired biodesign techniques, the project not only addresses the immediate issues of flooding and drought but also contributes to the long-term health and sustainability of the environment. This innovative approach highlights the potential of integrating natural materials and processes into modern design to create adaptive, resilient structures that benefit both nature and human society.
HOW CAN ADAPTATIONS TRANSITION LIFE INTO AN UNDETERMINED FUTURE?
HOW CAN WE DESIGN LIMINAL INFRASTRUCTURE THAT ALLOWS FOR ADAPTATIONS INTWO OPPOSITE EXTREME CLIMATE CHANGE CONDITIONS?
THE OVERALL VISION:
An interface between land and water that supports and sustains a diverse range of organisms.


PRECEDENTS + STUDIES
FOUNDATIONAL IDEAS
MEMBRANES
ENDOLITHIC
FOUNDATIONAL - INSPIRATIONAL - TECHNICAL
INTERSTITIAL SPACE
ENDOLITHIC ORGANISMS
WETLANDS ECOSYSTEM
Wetlands serve as an ideal model system due to their natural ability to manage and mediate water flow, filter pollutants, and support diverse ecosystems. These dynamic environments excel at balancing water levels, reducing the impacts of flooding and drought, and providing crucial habitat for a wide range of organisms. By mimicking the natural processes of wetlands, the project can create a sustainable interface that harnesses these benefits, ensuring ecological resilience and environmental harmony.

SALIX × FRAGILIS (CRACK WILLOW)


Crack willow is an ideal organism for our project due to its exceptional resilience and adaptability to varying environmental conditions. Known for its rapid growth and robust root system, crack willow can stabilize soil, reduce erosion, and effectively manage water levels. Its ability to thrive in both wet and dry conditions makes it perfect for creating a living interface that can mitigate the impacts of flooding and drought. Additionally, crack willow’s natural propensity for root weaving enhances the structural integrity of bioengineered designs, providing a sustainable solution that harmonizes with the ecosystem while supporting a wide range of organisms.
ECOLOGICAL INTERVENTION LIVE STAKING
live cuttings (0.5-1.5 inches in diameter)
Soil Bioengineering Systems
To restore and protect streambanks and shorelines, several effective soil bioengineering methods are commonly used. One method utilized in our design is known as live staking.
2-3 feet apart using triangular spacing
streambank
dead stout stake
Live Staking
Live staking involves inserting cuttings from living, woody plants, such as willow species, into the banks. These stakes have the ability to root and develop into shrubs over time. As they grow, they help stabilize the streambank or shoreline, contributing to the overall riparian habitat.
ARCHITECTURE & FORM
3D PRINTED FORM EXPLORATIONS





ARCHITECTURAL FORM,



EROSION PATTERNS & RAINFALL

Using Houdini software, erosion patterns and rainfall impacts on the surfaces of our designed architectural forms were meticulously analyzed. This powerful tool allowed for detailed simulations of how water interacts with the structures over time, providing insights into potential wear and degradation. By modeling these natural processes, the analysis helped identify areas susceptible to erosion and guided the optimization of surface designs to enhance durability and resilience. Understanding these patterns is crucial for creating sustainable structures that can withstand environmental challenges, ensuring longevity and stability in various weather conditions. This approach not only supports the structural integrity of the designs but also promotes their harmonious integration with the natural landscape.

2. FLOODING
1. DROUGHT
3. REGROWTH





HUMAN INHABITANTS

WILDLIFE INHABITANTS

CONTEXT


NEW GROWTH PHASE



CONTINUAL FLUX BETWEEN STATES TO MITIGATE EXTREME


02 DRY STAGE
REFLECTION
Why fight nature when it holds the solutions we need? The Interstitial Flows project challenges this mindset. Crack willow, a plant that thrives in floods and droughts, shows resilience and adaptability far beyond what concrete and steel can achieve. Its robust root system stabilizes soil and embodies natural intelligence perfected over millennia.
Wetlands, nature’s balance masters, filter water, manage flow, and support biodiversity effortlessly. Emulating wetlands teaches us that true innovation lies in collaborating with nature. Sustainable design should mimic these efficient natural systems.
Methods like biodesigning and root weaving are more than technical tasks; they represent a future where technology enhances, not dominates, nature. Advanced fabrication should work with natural processes, creating structures that blend seamlessly into ecosystems.
Creating interfaces between land and water to support diverse life is essential. Redefining efficiency to include ecosystem health, successful design gives back to nature, fostering spaces where biodiversity thrives and human and ecological needs coexist.
Traditional approaches fall short. Nature’s wisdom is vast, and ignoring it is futile. Sustainable design must recognize humanity as part of the natural world. Embracing biohybrid systems that integrate natural and engineered elements can lead to a future where human innovation enhances ecosystems. This is not just possible; it is urgently needed.


RAG_ODI
AITCH HUNT SOPHIA SALEKI GAYATRI JAIN





Drystone Walls of Chianti

Two-thirds of the Tuscany landscape comprises sloping terrain largely used for growing crops. Traditional drystone walls built in the 15th centrury are still, to a great extent, visible but generally in ruins. The technique of building and restoring dry-stone walls is timeconsuming and labour intensive and has led to over 70% of the walls collapsing and/or being abandoned (Agnoletti et al, 2018)
Naturally a new technique succeedeed and adoption of “steep-slope agriculture”, which relies heavily on mechanizaation, has become wide-spread, negatively affecting the hydrogeomorphology and the production ability of these lands.
We visited a farm in Italy where


the farmer is restoring to this day fallen down walls. He explained how since he began 10 years, he has observed the food chain become more complex, the soil become more fertile and overall the land become more healthy, by rebuilding the dry-stone walls.
Traditional dry-stone walls on a terraced farm maintain the health of sloped landscapes by reducing run-off and weathering by rainfall, relative to other hillside farming techniques. We also believe they harbour interesting microclimates and niches for a functioning ecosystem to be restored.

consequences
Hydrological
of terrace abandonment Figure from Moreno-de-las-Heraset et al, 2018.
Site Analysis


3D model from GIS data

Physical models of the site created with the layering of laser cut wood (top) and acrylic (bottom) 43.434582 11.401557



Digital topographical site models





FORM EXPLORATION IN RHINO
Creating terraces and a surface that is woven in, with spherical anchors

A less compliacted surface and larger anchors


Surface parallel to the ground (later to be rested on the terraces using houdini, with variable anchors
A larger surface and anchors along the perimeter


FORM DEVELOPMENT IN HOUDINI

The figure shows the evolution of form in houdini, changes were made to the the surface, anchor points and the script to make it more functional and aesthetically pleasing






Vellum solver with pins and gravitational force is used to form the catenary structure
Form-Finding
Physic-based


The design form was investigated through both top-down and bottom up based methods using physics and countours of the site terrain.

Top-down












Bottom-up







VISUALISED FORM



Anchored
Elevation A
Elevation B
Terraces


Catenary structure; a bi-product of gravitational force

Elevation C Anchored






BIOINFORMATICS
VISUALISATION & INTERPRETATION OF LIMESTONE MICROBIOMES






Proteobacteria
Bacteriodata
Actinobacteria
Cyanobacteria





Ascomycota
Cercozoa Basidiomycota
Study 1 - Porosity
A study to assess how porosity and empty space will affect the growth and composition of the microbiome of the subaerial biofilm. We expect there to be significant differences due to porosity affecting water flow and temperature etc.







Porosity increases.
Study 2 - Wavelength
A study to assess how different wavelengths will affect the growth and comunity composition of the subaerial biofilms on the limestone rocks.
Photosynthetic organisms use pigments that absorb light in the red and blue wavelnegths in order to function and tend to grow best in red light. We hypothesise that the yellow box will have a biofilm consisting of bacteria and fungi, and the red box will have the most abundant number of photosynthetic microorganism. Given that we expect there to be differences in the community makeup, we also hyposthesise there will be observable differences between the biofilms.


Inner layer of aggregates






Outer layer of aggregates

Middle layer of aggregates



Proteobacteria
Wall Ecology







60 - 120cm
0.2 - 10cm <8cm
2 to 10 µm
5 µm to more than 100 µm
1 to 100 µm
1 to 2 µm
Proteobacteria
Cyanobacteria
Algae
Ascomycota
Lichen
Moss
Vascular Plants
(1)
(2)
(3)

Growth on dry-stone wall from our site
(1)
(2)
(3)
Application of Bioinformatics to Aggregation Logic

More colour means there is a greater biodiversity of microorganisms. In this model we imagined that the difference in number of colours is due to environmental parameters.
In the radiation model you can see that one side has greater radiation relative to the other. We hypothesise that greater radiation would lead to a less diverse microbiome therefore represented by the green side. The more colourful side we would expect to correlate with the side with less radiation.




If greater biodiversity is desirable throughout the whole design then perhaps greater/less porosity is required where there is more radiation dependent on the affect it has on the microbiome of the drystone.
WHY LIME MORTAR?
Several examples of damages were attributed to the use of cement mortar when used with limestone. Researchers and construction engineers both acknowledge the importance of using a mortar with a chemical composition similar to the stones used in the construction and restoration of monuments, particularly when working with limestone. (Rautureau, 2001; Beck and Al-Mukhtar, 2008).
Lime mortar has similar pH and chemical composition as lime stone and since the project focuses on limestone walls, lime mortar was chosen as a suitable base for mortar synthesis.

(“Advantages of Lime Mortar - Civil Snapshot,” 2020)

EXPERIMENT: STARCH

Starch is a natural binder and naturally has a sticky texture. The use of starch in lime mortar can be seen in ancient China as far back as the 6th century AD. It is observed that sticky rice slurry was mixed with lime mortar to improve its performance. Addition of sticky rice to lime mortar is shown to improve mechanical strength till a certain amount, because, adding >3% sticky rice may act as a retarder for carbonization – absorption of CO2 to harden (Yang et al., 2010).
Use of sticky rice slurry with lime mortar in ancient China (Yang et al., 2010), led to a dive into starch as an additive to improve the mechanical strength of lime mortar. In this part of the experiment, 3 types of starches are mixed with lime NHL and a comparative analysis is done. It was observed that after a 4 days all the blocks developed a lot of cracks. The blocks with potato starch had developed the least number of cracks. The experiment was repeated (as mentioned under part 1). This time around, extra care was taken while forming the mixture to prevent addition of excess water and to maintain the workability of the mix. Once poured into molds, the molds were kept away from direct sunlight to prevent it from drying out too fast. It was observed that this time there were less number of cracks









Close to no cracks
Cracking observed
Control Potato peel starch Corn starch Sticky rice powder
EXPERIMENT: HYDROGEL
R P C M R + H P + H C + H M + H




For this part of the experiment, sodium alginate, potato peel starch, corn starch, sticky rice powder, NHL, building sand and water were used. . The mortars with hydrogel didn’t shrink, which was unexpected. The grass seeds did not die as fast in the mortar with hydrogel.
With hydrogel
Without hydrogel
Procedure:


NHL 121.75g sand

2.5 ml 4% Sodium alginate



Observation:
50g NHL 125g sand
Water
50g NHL 125g sand
Water
2.5ml 4% NaC6H7O6
48.5g NHL 121.75g sand
Water 5.25g Sp
48.5g NHL 121.75g sand
Water
5.25g Sp 2.5ml 4% NaC6H7O6
48.5g NHL 121.75g sand
Water 5.25g Sc
NHL 121.75g sand
Water
5.25g Sc 2.5ml 4% NaC6H7O6
48.5g NHL 121.75g sand
Water
5.25g Sr
48.5g NHL 121.75g sand
Water
5.25g Sr 2.5ml 4% NaC6H7O6
Result:
Grass seeds survived for longer with hydrogel
Control
Potato peel starch
Corn starch
Sticky rice powder
EXPERIMENT: WATER ABSORPTION
Observation:
Procedure:






Mortar sample weighed and submerged in water
2 hours Taken out of water and weighed after 2 hours

In 3 out of 4 cases the sample with hydrogel absorbed more water
Result:
Mr + H second highest water absorption %
Mp highest water absorption %

WATER RETENTION


Procedure:






Samples soaked in water








Mortar sample submerged in water
Removed from water after 2 hours
Weighed after 1D, 2D, 3D and 7D
Result:
Potato starch mortar with hydrogel loses water slowly and is able to absorb a substantial amount
Observations:

EXPERIMENT: BIO-COMPATIBILITY

Aim:
To grow biological species in accordance with bioinformatics research and to be able to encourage the grpwth using mortar.
Results:
The experiment failed as no growth was observed on the mortar. This can be due to alkalinit, non-porous nature and low-water reserves.
Procedure:










Nothing was observed even after 10 days

Grass shoot coming out of M +H
C. vulgaris Grass seeds
COMPRESSION TEST











Mortar with hydrogel without any starch performs the best under compression
Conclusions
Potato starch mortar performed well in case of water retention, water absorption and workability of mortar (less cracking), but it performed poorly in compression test.
Mortar with hydrogel, without any starch performed the best in compression tests and it performed admirably in water retention and absorption. So, the final mix selected was; Sand:lime :: 2.5:1 with 5% of 4% sodium alginate solution.
PART MODEL



Fabrication Logic &



Fabrication methods include the development of a process This entails an initial input of data through 3D scanning, systems of logic that are eventually converted into toolpaths
Methods
process for automation with irregularly shaped material. scanning, geometry processing and analysis of the data fed into toolpaths for robotic manufacturing.

Overview


3D Scanning



Process overview

Data Processing
Mesh data preparation

Proxy geometry

Feature Extraction & Cataloguing


Aggregation Logic
AUTOMATING CONNECTIVITY PLANES AND ORIENTATIONS ON EACH ROCK SURFACE

UTILIZING MESH CONSTRAINTS TO FORMULATE A LAYER-BY-LAYER TECHNIQUE


AND ARE BASED ON RULES


Support constraints require each rock to be supported by specific orientations and quantities of faces from other rocks
GLOBAL CONSTRAINTS USE SURFACE GEOMETRY OF TERRAIN, PREVIOUS ROCK LAYERS, AND ANY PRE-DEFINED DESIGN SHAPES


curves


volumes
These series of experiments examine the integration of constraints in three different forms: curves, surfaces, and volumes. These constraints can be used to influence the spatial configuration and density distribution of the aggregations. The relevance of this to drystone heuristics is the idea that the stone assembly will need to be continually influenced by changes in the local accumulation of layering and globally within the space-filling capacities of its environment.

combined conditions: slope, proximity to isolated curve, and surface terrain

boundaries
Shape attributes to generate rules
USING SHAPE FEATURES TO GENERATE AGGREGATION GRAPH THAT INFORMS ORDER OF OPERATIONS

LOGIC APPLIED TO LARGER-SCALED ASSEMBLIES



ASSEMBLY ORDER BASED ON RULES APPLIED TO IRREGULAR PROXY GEOMETRIES OF PROCESSED STONE MESHES

Heuristic-Based Optimization
RULES INFORMED BY DRYSTONE CONSTRUCTION PRINCIPLES ARE USED TO REDUCE THE SOLUTION SPACE PRODUCED BY DISCRETE DESIGN LOGIC

https://www.youtube.com/watch?v=IqH2xH_W4Y4&list=PLCn3_9Z4-E5A0EFluiMldlEbDufMiN1g
USE OF DRYSTONE HEURISTICS TO DEFINE RULES


0: R|0_R|8
TOP>BOTTOM
1: R|0_R|9
TOP>BOTTOM
2: R|0_R|10
TOP>BOTTOM
3: R|0_R|11 TOP>BOTTOM
4: R|1_R|8
TOP>BOTTOM
5: R|1_R|9
TOP>BOTTOM
6: R|1_R|10
TOP>BOTTOM
7: R|1_R|11
TOP>BOTTOM
8: R|2_R|8
TOP>BOTTOM
9: R|2_R|9
TOP>BOTTOM
10: R|2_R|10 TOP>BOTTOM
11: R|2_R|11 TOP>BOTTOM
12: R|3_R|8 TOP>BOTTOM
13: R|3_R|9 TOP>BOTTOM
14: R|3_R|10 TOP>BOTTOM
15: R|3_R|11 TOP>BOTTOM
16: R|8_R|0 BOTTOM>TOP
17: R|8_R|1 BOTTOM>TOP
18: R|8_R|2 BOTTOM>TOP
19: R|8_R|3 BOTTOM>TOP
20: R|9_R|0 BOTTOM>TOP
21: R|9_R|1 BOTTOM>TOP
22: R|9_R|2 BOTTOM>TOP
23: R|9_R|3 BOTTOM>TOP
24: R|10_R|0 BOTTOM>TOP
25: R|10_R|1 BOTTOM>TOP
26: R|10_R|2 BOTTOM>TOP

Physics Simulations
SCANNED ROCKS + CONTAINER GEOMETRY + GRAVITY









PREDEFINED WALL + PHYSICS = GENERATIVE IRREGULAR GEOMETRIES

Genetic Optimization
Genetic algorithm are used to artificially select optimal traits from a population of possibile variations. The below images show a genetic optimization being used to minimize deflection values based on rock placement



Placement of rock layers optimized through genetic algorithm to maximize surface contact and minimize overall movement of structure



Robotics System Overview



robot
gripper
workpiece






Continuing picking and placing rocks until desired structure is obtained
Step 1: pick 1st rock
Step 2: Place 1st rock
Step 3: Return to home position
Step 4: Pick 2nd rock
Franka Emika Robotic Arm

Calibration Plane orientations


Toolpath generation

Robotic toolpaths are created from a the aggregation logic demonstrated in previous pages. The order, orientation, collision, constraints, predefined geometries, and heuristicsbased rules/optimization are all factors used to inform the network of paths used to generated structures from found materials

Robotic Gripper

Closed with workpiece

Collision considerations




Gripper Design




Workpiece Progression
regular geo with identical faces






irregular rock assembly


Design + Assembly Logic

Controllable Parameters for Bio-Integration
heterogeneity


random vs rule-based assembly

density & proportions

Porosity via Proxy Geometry




geo as rocks




Proxy
Radiation-Based Assembly


Architectural Integrations
Drystone Typologies
Recreated typologies using assembly logic








Corbelled Vault Drystone
















// PROJECT MEMBERS
LIU, FRAN SALEKI, SOPHIA HUNT, AITCH
// PROJECT TUTORS
BOMBELLI, PAOLO; DEVADASS, PRADEEP; LE, TONY; RUIZ RODRIGUEZ, JAVIER; SALAMANE, ANETE
Y A
R O C W E H & T D


LIU, FRAN. MArch // architect
BACKGROUND // As an architectural designer graduating from MArch in TKU university(2022), Liu’s work expands from the realm of human interaction in urban context, to the engagement of psychology, ecology and biology of spaces.
LEAD // BOTANY RESEARCH + GRAFT AND JOINERY RESEARCH + FABRICATION + SPATIAL DESIGN + VISUALISATIONS
HUNT, AITCH. MSc // bio-computation
BACKGROUND // with a dual major in plant biology and game development from NCSU (2021), Hunt’s work largely focuses on the optimization of advanced technologies for improved collaborations with the local ecosystem.
LEAD // ASSEMBLY LOGIC + STRUCTURAL ANALYSIS + COMPUTATIONAL OPTIMIZATION + GRAFT AND JOINERY RESEARCH

SALEKI, SOPHIA. MSc // biology
BACKGROUND // BSc in Biological Sciences from the University of Bristol (2022). Sophia’s focus spans analysing bioinformatic data, ecology, and environmental data to enhance the use of living systems in design.
LEAD // WOOD DECAY FUNGI RESEARCH + BIOINFORMATIC ANALYSIS OF BIOLOGICAL DATA


ABSTRACT
The Growth and Decay project involves developing an innovative architecture design for an outdoor music festival installation in Epping Forest. This structure integrates living, dead, and decaying tree wood components, inspired by state-of-the-art research such as Wood Chip Barn, Plane Tree Cube, and Tree Fab Hub. The project promotes the full life cycle and ecosystem of the materials used, divided into three main components:
1. The Living: Tree shaping and grafting of growing London Plane trees around a scaffolding.
2. The Decaying: Programmable wood decay through optimized pattern illed into dead tree wood components.
3. The Dead: Locally-sourced tree branches, 3D scanned, and assembled into a supporting scaffold.
Two joining methods are utilized: natural branch junctions combined with cross lap joints, and guided grafted joints using inosculation or whip and tongue grafting. The chosen tree species, London Plane and willow, are selected for their high availability and ease of shaping and grafting.
Advanced fabrication methods involve a 6-axis robotic arm for cutting joint geometry and surface patterning to control decay. The scaffold guides and supports the living trees, with tree growth simulations ensuring stability and optimization of weak structural points. Assembly logic employs computational algorithms to analyze and sort 3D scans of wood pieces, optimizing structural stability, environmental conditions, and design requirements.
The structure is designed to encourage activities such as climbing, collaborative lounging, and private lounging, with architectural conditions tailored to promote varying levels of light penetration, enclosure, density, and spatial elements. The project exemplifies a harmonious integration of natural processes and advanced technology, fostering a sustainable and dynamic architectural environment.
00 // INTRODUCTION
01 // STATE OF THE ART
02 // THE LIVING
03 // THE DECAY
INTRODUCTION



“Plants age and rejuvenate, a trunk can live for centuries, a branch might last weeks. This rhythm gives plants a sense of time.”
AGE OF ASCENT
Architecture, the constructing of human spaces, was originally defined by Roman architect Marcus Vitruvius as a building or an object structurally sound, functional and beautiful(utilitas, firmitas, and venustas). Overtime, the concept of architecture has evolved and shapeshifted throughout different civiliations and movements. During 1930s, “Form Follows Function” replaced ornamentation and become the golden principle for architectural design under the influence of Industrial Revolution. Human living spaces were designed highly functional and efficient in material. However, Nature wasn’t considered a part of the efficiency in human’s living until the monotonized industrial culture began to damage our ecosystem.
In the late 50s, metabolism and biophilic architects began to perceive architecture as a growing, adapting entity, almost alive. Co-existing harmoniously with other living beings became the new efficiency as apposed to the modernist’s effiency. Forms are now adapted and evolved to enhance biodiversity and bioreceptivity, whilst shaping our day-to-day living spaces.


Within the last few centuries, human technology and intelligence has progressed far more than we could have imagine. As our knowledge expands, the architecture of the universe began to unveil itself. Our perception of time and space in nature was liberated from the present world we see, when Darwin discovered how species were evolved to adapt over time. In 1917, D’arcy Thompson continued to publish “On Growth and Form”, unveiling the transformation of life forms under the influence of physical forces. In 1952, Alan Turin further published a paper titled “ The Chemical Basics of Morphogenesis”, describing and basic reaction diffusions are the fundamental sources of natural forms. Life forms are, in fact, the representation of forces and energies of the universe. Since then, the world is percieved as an everchaning emergence. Each being closely intertwined and linked to others.
How do we locate and adpat ourselves as human beings?

THE LIFE & DEATH OF TREES


THE METAPHYSICS OF TREES
As human beings, our way of perceiving and growing with time is linear. As we age, our cells multiply, forming a body, limbs and organs. With time, we start to decay, until eventually we cease to function. Plants, however, appear to exist in a rather peculiar limbo between life and death.
EVOLUTION OF TREE
In a typical tree, more than 80% of the tree bark is in fact dead. The dead tissue gives shape, supports and solidifies the tree. Plants can reproduce sexually and asexually through means of flowers, seeds and fruits, referred to often as propagation. Seeds can stay dormant for many years before awaking and sprouting into a new plant. The extraordinary ability of interplaying, complementing between the living and the dead allows plants to extend their lives almost infinitely. The timeline of a tree seems to be multi-sectional. The trunk lives throughout the entire lifespan. However the branches grow and decay in relatively short period of times. Through these attributes trees are able to distribute energy with high intelligence, at the same time, live symbiotically with other beings, thriving with the ecosystem.
Angel oak, a southern live oak located on Johns Island, S.C., is an estimated 400 to 500 years old. Credit: Dawna Moore Alamy
ORGANIC RESEARCH


In a typical tree, more than 80% of the tree bark is in fact dead. The dead tissue gives shape, supports and solidifies the tree. Plants can reproduce sexually and asexually through means of flowers, seeds and fruits, referred to often as propagation. Seeds can stay dormant for many years before awaking and sprouting into a new plant. The extraordinary ability of interplaying, complementing between the living and the dead allows plants to extend their lives almost infinitely. The timeline of a tree seems to be multi-sectional. The trunk lives throughout the entire lifespan. However the branches grow and decay in relatively short period of times. Through these attributes trees are able to distribute energy with high intelligence, at the same time, live symbiotically with other beings, thriving with the ecosystem.

SUBLIME IN THE DIGITAL AGE
“The sublime moves us supremely than the beautiful...We are forced to face our insignificance and there is something both terrifying and exciting about that.”
Edward Burke
The art of sublime begun in the 1800s when Romanticism was largely concerned with the untamed power of nature. Connecting nature with god, the horrifying yet mysterious figure that dominates over human beings. According to Kant, things that are massive and overwhelming are not in fact what is sublime. The sublime is the relation of these things to the concept of totality and freedom. The reasoning and philosophy behind is mysterious and alluring.
The beautify of the unknown.
The sublime forces us to confront the grandeur of a larger entity, may it be god or nature. It challenges our prespectives.


As bio-designers we have to ask ourselves,
How much do we understand nature?
Where is the end of our design?
Where do we begin with?
To what extent can we live with the ever changing nature?
These questions simply cannot be solved with straight answers, but numerous attempts, trials and iterations. The design is at the same time evolving to reveal its own truth.The digital age has challenged our preconceived notion of design, shedding lights on the utopian vision of living architecture. Spaces, relations, data can now be accurately monitored and documented with tools such as 3d scanners, bioinformatics, environment simulating softwares. The growth and decay of organisms, materials, spaces are no longer a mystery unsolved, but graspable, parameterizable data within our reach. To decide whether to align the growing of our human spaces with nature’s language, or to create the different playful dynamics between us and nature thus become one of the main experiments in this project.
TREE GRAFTING






Plant grafting has been practiced for over two milennia across Asia and Europe and is one of the oldest agricultural methods used in horticulture and fruit orchards. Grafting, simply, invloves attaching the shoot of one plant (the scion), onto the stem of another plant (the rootstock). The peeling back of bark induces wound heeling which ajoins the two different plants. Due to the different plants being able to exchange whole genomes via plasmids, desirable traits of the scion and rootstock can be interchanged and give rise to hybrid phenotypes that benefit humans, for example.
NATURE & CONTROL
Ancient heuristics to future logistics
The tension between controlling nature and allowing it to flourish reflects a fundamental shift in our approach to design and construction. Historically, methods like those used in building living root bridges in India exemplify how humans have harnessed natural growth processes to create sustainable, living structures. These bridges, made by guiding the growth of tree roots over decades, demonstrate a harmonious relationship with nature where human intervention facilitates rather than dominates. Similarly, ancient shipbuilders would select trees whose natural curves and strengths suited the form and function of their vessels. This practice not only respected the intrinsic qualities of the wood but also ensured that the end product was robust and reliable. Both examples highlight a deep understanding and respect for nature’s inherent capabilities, showing that by working with natural forms and processes, humans can create functional and enduring structures.

Selection of wood for shipbuilding, from: Encyclopédie méthodique, Paris 1787 (scanned page from: Broelmann, J.: Schiffbau –Handwerk, Baukunst, Wissenschaft, Technik). Source: ‘Deutsches Museum, München, Bibliothek, 2000/Gesch. 650.109’.
Today, we are translating these ancient heuristics into modern logistics through robotic fabrication and advanced computation. By studying and mimicking these time-tested methods, we aim to integrate natural growth patterns into contemporary design and construction. This involves developing algorithms that can analyze and optimize the natural forms of trees, allowing robots to replicate these processes with precision. Such an approach not only enhances efficiency but also promotes sustainability by reducing waste and utilizing the natural strengths of materials. By collaborating more closely with nature, particularly with trees, we can create living, adaptive structures that benefit the environment. This shift towards a more symbiotic relationship with nature holds the promise of living harmoniously within our ecosystems, fostering a future where human activities contribute positively to the natural world rather than depleting it.

https://en.wikipedia.org/wiki/Living_root_bridge
STATE OF THE ART



veteranization arborculture association


spalted wood Hugh Morris
YURE Kengo Kuma.
conceptual joining Lukas Allner.

Fab Tree Hab
Terreform ONE



veteranization arborculture association


tree chair
Gavin Munro
wood chip barn
AA hooke park
tree pavilion
Baobotanik
ARBORSCULPTURE
LIVING ROOT BRIDGE

In ancient times, the workship of nature was mankind’s central belief. The Khasi people, one of the oldest indigenous tribe resided Meghalaya in north-eastern India (Ludwig, Middleton, Gallenmüller, Rogers & Speck, 2019; Shankar, 2015), has been known to utilise tree roots’ growth to create living bridges for centuries. In the remote tropical mountain rainforests, they weaved the aerial roots of trees into the main supporting structure of bridges, in order to cross the deep gorges and rivers. As the tree roots grow, they begin to merge and inosculate into truss-like structures, while flat stone slabs are installed between to become walking surfaces. The bridges can span from 20 m to 53 m. They are manufactured and grown for around 15 and 30 years, and remain functional for several centuries, (Shankar, 2016)


The rubber trees(Ficus elastica) were initially planted on two sides of the river banks, stabilising the soil structure with their roots. When they are grown into certain heights, temporal supporting structures made of bamboo are constructed as scaffolds along the tree trunks for ariel roots to grow onto. The roots are continuously knotted into a dense network before they thickens and take over the supporting scaffolds.
The structure not only serves




The living root bridge has been frequently referenced in the realm of bio-design, as it provides the humblest way of taking advantage of trees’ secondary growth and malleability. The construction requires no advanced digital technology, but a constant care and interaction between human and the tree. Without superimposing an ideal form of bridge, the planting, scaffolding and knotting techniques allow, and respect trees to flourish in their own ways, hence connecting further to the forest ecosystem. The structures are covered with mosses, fungus and microorganisms, which helps the degradation of structure back into the wood land cycle.
reducing carbon footprints by using living wood why is it not considered? what can digital tools help us?
TERREFORM 1
FAB TREE HAB

The Fab Tree Hab directed by Mitchell Joachim, Lara Greden and Javier Arbona from Terreform and MIT the Media Lab has attempted to establish a new symbiosis between human living space and its surrounding ecosystem. The project overturns the traditional concept of a house being a shelter from exterrestrial environs, instead they proposed utilizing grown local trees as a longer and healthier way of growing homes.
Trees such as Elm, Live Oak and Dogwood has fascinating self-grafting feature, namely inosculation. They are designed in the Fab Tree Hab House to grow, inosculate into the load bearing structure of the house. The branches are then pleached into walls and roofs infilled with thermal clay and straw for insulation and blocking moisture. Prefabricated Computer Numeric Controlled(CNC) reusable scaffolds are made as a framework to guid the tree growth.






In nearly two decades of fab tree hab research, Joachim and his colleagues has created several iterations of tree grafts, scaffolds and spaces for multispecies. From The One Lab, to project Home Alive, to Fab Tree Hab House in built in 2023, different elements of design were discussed. The One Lab was a non-profit group established from 20092020 focusing on urban communities, and developing its pedagogy that opens the dialogue between ecological architects, urban planners, civil engineers and local communities. Project Home Alive is a research investigating in grafted willow trees as Engineered Living Material(ELM) and the potential of microorganisms being incorporated into biomaterial, such as a matrix like biofilm using techniques like 3d printing, spinning or microencapsulation.
In 2023, The studio built the multispecies living structure in New Windsor, New York, with a foorprint of approximately 93 square feet.
The structure serves as an observatory, education centre, and habitat for wild life. First two rows of 30-foot-tall willow trees were planted on both sides of the structure, later on weaved and grafted with the CLT frame. At last modular units made from crocheted jute fibres and 3D- pinted bioplastic pockets were installed to create micro habitats with the aim of enhancing biodiversity.
The project has a fascinating approach of co-designing with time, and enhancing the growth of ecosystem through multimateriality and pocket spaces. The trees being grown in two different heights also helped expediting the grafting process. However, the interaction between living and dead wood was left unaddressed. How can the decay of wood and new growth of wood compensate, support or guide one another hence become one of the main focus in our research investigation.
TREE SHAPING
TREE CHAIR
Gavin Munro and his company Full Grown has been growing tree furniture since 2012. The concept of shaping and grafting tree spaces seeded from the resemblance of a bonsai tree accidentally grown into a chair shape, and the bone grafting surgeries he went through in his childhood. The growth of beings and how we and other species adapt spatially with time is a beautiful poetic aspect oftentimes neglected in the spaces we dwell in.



Utilizing the biological process of guiding and manipulating tree growth to form functional structures, such as chairs. The progression from sapling to mature tree is considered in different stages, reflecting a timeline of growth and form manipulation.
At the earliest stage, young saplings with flexible branches are trained into predetermined shapes. As the growth continues, the branches are systematically directed, often using supports or molds, to gradually take on the contours of a chair. The process involves grafting in the later stage, where branches are joined together to grow as one, and inosculation, a natural phenomenon where trunks or branches in close contact irreversibly enterwine.
Dietel Chair, 2012-2016. Permanent collection of MAD - Musée des Arts Décoratifs, Paris.
For decades Gavin developed several methods of furniture shaping, utilizing rope binding, metal scaffolds to guide trees’ growth. The process of growing a chair takes overall between four to eight years. While comparing to the process of harvesting, cutting wood and fabricating in conventional wood furnitures, the tree chair has a much more elegant efficiency, at the same time better coopoerative with the natural world.
The project is a delicate dialogue between trees and human. It has demonstrated endless possibility of tree shaping into human spaces, without cutting pieces of wood into standardized geometries but utilizing the natural morphology of trees. The trees, thriving as they grow, are eventually cut down and processed into furniture. And new trees are planted. Turning the garden into an interesting tree farm. However is there a way to co-create spaces and objects with trees without ending their lives? Can we consider the continuous growth and maintaining process into the making of a space? These are the questions we attempt to address in our project research.


RECURSIVE AGGREGATIONS
CONCEPTUAL JOINING

The “Conceptual Joining” research initiative at the University of Applied Arts Vienna focuses on innovative wood construction techniques that merge traditional craftsmanship with digital design and fabrication methods.
This project explores the use of interlocking wood connections and complex joinery, optimized through both empirical design processes and advanced computational methods.
Researchers aim to develop sustainable, efficient, and structurally innovative wood assemblies that challenge conventional construction practices, drawing on interdisciplinary collaboration to push the boundaries of architectural design and material science.

The diagram to the left shows a geometrical analysis of a tetrahedral cell formed from a standardized “proto-part” that will be used to represent various categories of branch sizes in a discrete manner.

The above images demonstrate the pattern differentiation between aggregations containing different sets of rules. These logistics explore the application of 2 domains of assemble logic. The first domain encompasses catalogue sorting at the individual level of each branch and its physical properties. The second domain considers logistics at the global level of assembly, following optimial construction strategies.
IRREGULAR INVENTORIES
STRUCTURAL UPCYCLNIG

This research, by MIT Digital Structures, focuses in on a new method of optimization of locally sourced tree wood through the use of nodal geometry and matching algorithms.
After 3d scanning and digitally inventorizing the tree branches, each model is processed and converted into an abstraction of relevant geometrical features such as bifurbication angles, vector directions from center, and cross section diameters.
The centroid of each branch is converted into a standardized node model that utilizes wood grain flow and its relationship to material strength


The optimization method in the paper focuses on matching and optimizing the use of tree forks for structural nodes in spatial structures. It utilizes a computational algorithm to match each tree fork from a digital material library to specific nodes in the design geometry, aiming to minimize a mismatch error based on a quantitative matching score. This score is integral to an optimization process that balances the use of natural resources with the design’s structural and aesthetic requirements. The algorithm iteratively adjusts the design to improve the match between the available material and the structural nodes, ensuring both resource efficiency and fidelity to design intent.

LIVING ARCHITECTURE
BAUBOTANIK
The Baubotanik Footbridge uses tree growth and inosculation to create a walkway whose foundation is made solely from living basket willow (Salix viminalis), designed by Ferdinand Ludwig and Oliver Storz and later realised with Cornelius Hackenbracht. The orginal structure comprised of 64 vertical bundle supports, however, due to competition and other important environmental factors such as lack of sunlight there was successive loss of indiviual and vertical bundles over time. Throughout the process of maintaining the structure, ongoing human intervention is required, either in pruning or cultivating new shoots to replace dying bundles. This is an example of the interconnectedness of nature, as not only do humans guide the trees but the trees also guide the humans each year.





ARBORSCULPTURE
DESIGN WITH DECAY




Wood Wise • Woodland Conservation News • Spring 2014





Making Hollow Trees. Wainhouse
M.
Boddy L. 2022
RESEARCH & EVOLUTION
The journey of the Living and Decay project was marked by an extensive process of exploration and iteration. Initially, the research encompassed a broad spectrum of ideas, ranging from traditional construction methods to cutting-edge bioengineering techniques. Early stages involved studying the natural cycles of growth and decay in various ecosystems, as well as the potential for integrating living materials into architectural design. Through a series of experiments and prototypes, the project evolved, constantly refining the balance between aesthetic, structural, and ecological considerations. Each phase of research brought new insights, leading to innovative approaches in using living and decaying wood to create sustainable, adaptive structures. This iterative process of ideation and experimentation ultimately culminated in a design that not only met functional requirements but also harmonized with the natural environment, embodying the project’s core vision of creating living architecture.



PROJECT OVERVIEW







































BIOLOGY















RESEARCH NAVIGATION
The relevent researches are mapped out within this century. Inspired by the growth of a tree ring, the map shows as time goes, how the different research focus expanded in each research and how they start to corelate with each other.
arborsculpture
CONTRIBUTIONS OF OUR RESEARCH


Kröhnert, D. (n.d.). Conceptual Joining: Branch Formations. Retrieved May 27, 2023, from https://www.academia. edu/37719834/Conceptual_Joining_Branch_Formations
https://fullgrown.co.uk/
Amtsberg, F., Huang, Y., Marshall, D. J. M., Moreno, K., & Mueller, C. (n.d.). Structural Up-cycling: Matching Digital and Natural Geometry.
Zachary Mollica, Martin Self, Advances in Architectural Geometry 2015 – Tree Fork Truss: Geometric Strategies for Exploiting Inherent Material Form”, 2016, https://doi.org/10.3218/3778-4_11.
Ludwig, F., & Schönle, D. (2022). Growing architecture: How to design and build with trees. Birkhäuser.
Arbona, J., Greden, L., & Joachim, M. (2003). Nature’s technology: The fab tree hab house. Thresholds, 48-53.
RESEARCH MAPPING
MATERIAL MAPPING















Organisms
Ecology
Life Cycle
Festival
Material

















SITE-BASED DESIGN
TOPOGRAPHY ANALYSIS

potential sites





Since our design is intended to integrate both the living trees on site and their dead counterparts collected as wood material, it is necessary that the layout and geometry of existing trees be incorporated into the predefined architectural typology.
One way to accomplish this task is to use photogrammetry to capture a 3D survey of the intended site. From this 3D survey, a sitespecific design can be generated that utilizes the various geometries of the trees and the topography of the landscape.
Our explorations consider the available points of connections at the ends of tree branches, the potential connections that can be made between these points, and the resulting cell panel geometry created from these framing methods. This is done by extracting the centerlines from the models of trees and their branches, assigning points to the start and ends of these lines, and applying various methods of triangulation between these points. These methods of triangulation use Delaunay, Voronoi, and weaving patterns to achieve different results varying in angular and organic geometries. Each of these triangulation methods also allow for parameterized adjustments within their networks.
Epping Forest
Richmond Park
London



ITERATION 01
OVERVIEW


FROM CONCEPTUAL TO TECHNICAL
The project stemmed from our immense interests in the peculiar life of plants, from micro to macro scale, to the oak tree ecosystem, to the various technical ways of analyzing and co-creating spaces with oak trees and mycelium.
There were two phases in the development of this project, starting from plants propagation with bamboo and willow, we explored the joining and aggregating logic of plants. At the same time exploring a facilitative mycelium structure using topology optimization. In the second phase, we centred on the keystone species oaks, due to its structurability, contribution to the establishment of woodland habitat and symbiosis with heart-rot fungi. Using 3d scanners and structural analysis, we explored different ways of analyzing an inventory of tree trunks and branches. Extracting attributes to further inform the design of a structure. The assembly and aggregation of structure is then informed by human activities and joinery types. On the other hand, mycelium is cultivated and tested for futher fabrication such as slip cast and 3d printing. To explore further experimentation on various texure developments.


























5. timber x clay scanning

3.

4.













MAPPING
nature of plants

plant ecology




Mediating Irregularity: Towards a Design Methods for Spatial Structures Utilizing Naturally Grown Forked Branches Allner L. et al., 2022 robotic fabricaion computation





Making hollow trees: Inoculating living trees with wood-decay fungi for the conservation of threatened taxa - A guide conservationists
Wainhouse M. et al., 2022



MyCera. Application of mycelial growth within digitally manufactured clay structures Jauk J. et al., 2022 construction material computation scanning 3. 4.


Conceptual Joining wood structures from detail to utopia
Allner L. et al., 2022
CHOSEN METHODS
The two species bamboo and crackwillow were propagated through cutting and airlayering methods. We created four comparison groups, depending on whether the sample is growing in water or soil, and whether it is dipped with root syrup or root syrup with myccorhizal fungi. At first we tried to preserve the leaves and branches from the cut culms, but through documentation we discovered they were severly dyhidrated and didn’t seem to have enough energy to grow. Therefore, we further remmoved the excessive branches and leaves to allow the cut culms to grow with the root growth syrup. Experiments were documented every five days.


2 WEEKS
>6HR SUNLIGHT
>13 DEGREES
EXPERIMENT DOCUMENTATION



































LOADING AND SUPPORTING POINTS






MAT A - BAMBOO
MAT B - MYCELIUM CLAY

ITERATION 01
STRUCTURAL OPTIMIZATION

We started from the exploration of loading and supporting areas. from single to single points, to multiple to multiple points. And exploring the different loading areas such as, point, line, faces. The optimization of topology creates the more efficient shape according to various settings, including resolution, analysis parameter, threshold settings.
A set of nine units of structure was created to imagine the interplay of mycelium structure with bamboo culms. They were assembled according to points, lines, and faces, into a porous and dynamic space.
ASSEMBLY & AGGREGATION















Assembly of these locally-sourced and scanned materials requires an optimized blueprint to guide placement, stability, and overall arrangement within a design. Parametric modeling is an ideal method for predefining an architectural typology best suited for types of structures the material most accurately represents. For example, tree trunks most similarly represent beams in that their structure and function have evolved to hold most of the weight of a tree.
Tree branches can be compared to spatial frames due to their branching and connection patterns. This architectural typology is then parametrized through a network of adjustable properties that can be optimized for the best solution available from a limited inventory of components. Adjustable design parameters used in the following parametric models include the number and type of connecting nodes and the distance and angles between connections. Manipulating these parameters will cause global changes to the overall size and shape of the design, allowing an optimized form to be found from a given inventory of non-standard building elements.









ASSEMBLY & AGGREGATION ITERATION



branching attachment at nodes



angle constraint proxy geometry
attachment point

bamboo stochastic aggregation at its max capacity of parts that can meet all of the connection, orientation, and boundary conditions of the design

permitted areas of growth and is dependent on base topology, architectural design, and aggregation pre-conditions



rhizome aggregation serves as the base plane constraint to control initial attachment conditions and the behavior of aggregation growth detailed rhizome geometry



















ITERATION 01
STAGE I DESIGN




SPATIAL ARRANGEMENT
TOPOLOGY OPTIMIZATION I

In the first phase, the structure was designed from the optimization of outer geometry. According to the desired spaces, we first arranged the spaces and optimized the form through TOPOS. Using solar analysis, we decided one that has the maximum sunlight above and below structure. Then we imagined how bamboo rhizomes and branches can be aggregated and gradually filling up the voids through WASP. Later with the bamboo structures, we conduct structural analysis to decided where to grow the mycelium supportive structure.















STRUCTURAL







BAMBOO STRUCTURE
STAGE I PROPOSAL
The project aims to design a festival structure that is ever growing, interacting with the forests. The site was set at Lincolnshire in the first phase of design, where the lost village festival happens every year. The space contained three parts mainly: performance stage, DJ sets, audience’s seating. With different elevation of the spaces, people are able to view and experience the trees and music from various perspectives.


TOPOLOGY OPTIMIZATION













PERFORMANCE DJ AUDIENCE CAMPING
INTERACTING WITH NATURE SHOPS
WORKSHOPS FOOD BARS







































PARAMETRIC EXPLORATIONS

Optimization takes place on two levels. The first round of optimization uses iterative closest point and the Hungarian matching algorithms to compare the available inventory of scans to the initial architectural design. Each comparison is given a score based on how closely it aligns with the design. After all pieces are compared, scored, and ranked, they will be assembled into a close representation of the predefined parametric model.


The second round of optimization selects designs based on mandatory preconditions that need to be met such as a load-bearing capacity for structural stability. If all of the available solutions from the first round of optimization do not meet these requirements, adjustments to the design itself will be adjusted and looped back through to the first round of optimization until a suitable design and arrangement of elements is generated.




PARAMETRIC EXPLORATIONS
























































































SPATIAL ELEMENTS:







itr_00
itr_01
itr_02
topos calculation


STRUCTURAL VISUALISATION


ITERATION 01
DESIGN PROPOSAL
The project proposes a structure living and growing within the forests, fostering the thriving of local micro habitat. At the same time hosts as a festival space, providing playground and stages for people to indulge in.
The structure contains two parts: tree branches and fungi. The planted and grafted trees become the main frame structure, while the printed mycelium substructure and fabrics serve as secondary function, providing coverings, cavities for small organisms to dwell in.
Through time, the structure is envisioned to continue to grow and decay, providing new opportunities for future activies in the festival.


THE LIVING
Trees are known to evolve around 350-400 million years ago(1), at a time where low-lying plants were thriving and rich organic soil are developed due to the cycling of nutrients.(2) The trees developed extraordinary structure and the ability to maximize photosynthesis process. They became home to 50 percent of the world’s known animal and plant species. The forest also provide 50 percent of the world’s carbon storage. Human also rely heavily on wood timber for constructing houses and infrastructures.(3), which has contributed to serious deforestation and habitat loss issue nowadays.
https://treescharlotte.org/tree-education/abrief-history-of-trees/ https://www.britannica.com/plant/tree/Treestructure-and-growth https://www.bournemouth.ac.uk/ news/2022-09-22/new-research-has-revealed-importance-trees-humanity-warning-loss-trees-could-lead-ecological-economic-catastrophe


TREE MORPHOLOGY
In order to comprehend and co-create with trees, the morphology of trees are studied to understand the relation of form and fuctions in a tree structure. Trees are constructed by three main organs: the roots, the stems and the leaves. The leaves are in charge of photosynthesis in most higher vascular plants. Through the vascular system, oxygen and carbohydrates from photosynthesis are exchanged with nutrients and water to other various parts of a tree.
The root anchors the tree into the earth to prevent it from topping over. With a dense network, roots are able to absorb water and nutrients and often times in association with mycorrhizal fungi to increase phosphorous uptake.
The stem is composed of nodes and internodes, one are points where leaves are attached, the other are the lengths of the stem between nodes. Stems provide structural support, water and nutrients conduction for the whole tree.
main shoot apex
axillary bud
axillary shoot leaf
stem with young periderm
dormant bud
stem with scaly bark
taproot with periderm
lateral root root hairs

pith primary xylem vascular cambium primary phloem cortex epidermis
pith primary xylem secondary xylem vascular cambium secondary phloem cork cambium cork bark
The stem, which takes up the majority volume of a tree, are mainly formed by two pipe-like tissues: xylem and phloem. In between primary xylem and phloem lies the vascular cambium where growth takes place. As tree stem grows and expands, the inner xylem tissues dies and forms the heartwood. The rest of the living tissues are sapwood. On the outer layer of stem there is cork cambium. It produces cork and secondary phloem to form a protective layer, namely bark. According to a research from Costa Rica, the proportion of heartwood ranged between 0.4% to 61%.(1) And it increases as a tree matures, leaving the tree structure in an ambiguous state between life and death.
https://www.researchgate.net/ publication/242180569_Heartwood_Sapwood_ and_Bark_Content_and_Wood_Dry_Density_of_ Young_and_Mature_Teak_Tectona_grandis_Trees_ Grown_in_Costa_Rica#pf4
TREE MORPHOLOGY







simulations and factors
Trees were studied and recreated in Houdini with data collected with regard to various characteristics in different stages of tree growth. The tree generator is a toolset created by SideFX Labs to simulate simple tree growth with tree trunks, branches and leaves. The first sets of exploration focused on utilizing the tree generator to visualize the two different species and their growth in four different stages.




TREE MORPHOLOGY
Lsystem branching morphology
n
n
angle: 25°
F: draws forward
-: turn right 25°
+: turn left 25°
[: save current values for position and angle
]: pop the stack and reset the position and angle




In this research project, we focused on two tree species: London Plane and Willow. London Plane tree is a hybrid plane tree between oriental plane(Platanus orientalis) and American sycamore(Platanus occidentalis), which is a commonly planted urban tree in Europe and the US, due to its fast growth. The tree has high tolerancy towards atmospheric pollution and root compaction and is relatively wind-resistant. The tree is often pruned by pollarding to create club-like branches and limit the growth height of a tree. Willow trees, of the genus Salix , are known to be found in cold and temperate regions with moist soils. Willow trees have slendor, flexible twigs. The branches have relatively higher fall off rate, which is one of their strategies in resprouting.
The two trees are mentioned in the research of Baubotanik. They are recorded to perform better in inosculation and grafting.
monopodium & sympodium
alternate & opposite branching
&
hypotony, epitony & amphitony


dichasium
monochasium
acrotonic & mesotonic basitonic mesotonic acrotonic
four stages of life
TREE MORPHOLOGY
A tree’s life can be categorized into four stages, embyonic, junevile, adult vegetative and adult reproductive. A typical London plane tree can live for more than four hundred years, while a willow tree around three hundred years. As they transit into adult vegetative stage, they start producing branches with wider angle to increase the crown diameter, while growing upwards until around 15 meters. London plane trees enter adult reproductive stage later when they’re around 30 years old, while willow trees earlier in their twenties. London plane trees can grow up to 35 meters tall, while willow tree around 25 meters.



1-5 m Diameter: 1-3 cm
cm
5-15 cm
45-60
1-3 mm

Height: 5-15 m Crown Diameter: 5-10 m Stem Diameter: 5-15 cm
girth: 35-40 cm Leaf Length: 10-20 cm Bark Thickness: 3-8 mm
Branching Angle: 60-90




Height: 15-30 m Crown Diameter: 10-20 m
Stem Diameter: 10-30 cm girth: 89-90 cm Leaf Length: 10-20 cm Bark Thickness: 5-10 mm Branching Angle: 75-90

ADAPTATION
Trees are extraordinary successful living organisms, highly adaptive to the various changing environments. They usually respond to their surroundings primarily by morphological and physiological responses, as well as by reallocating available nutrients and water to those organs in most need. According to research from Forestry Commission Research Agency in Scotland, trees have four main system requirements their adaptations centered on, which are photosynthesis, reproduction, mechanical stability, and hydraulic exchange.(B.A. Gardiner and C.P. Quine, 2000) In order to understand and simulate tree growth under multiple environmental and artificial factors, we started by looking into how simulations can be articulated to project tree’s response mechanisms to given environmental factors such as light, loading and wind.
https://www.britannica.com/plant/ tree/Adaptations
https://www.researchgate.net/ publication/290999711_The_ mechanical_adaption_of_tree_to_ environmental_influences

“The
growth, structure, and composition of a forest are a function of the intensity and quality of light streaming into it. Trees partition the light resource in time and space.”
TREE GROWTH SIMULATION
TREE ADAPTIONS
This diagram illustrates an exploration into the various adaptations that trees have undergone over time, evolving into the complex, diverse, and durable organisms they are today. For this analysis, Houdini software and a specific plug-in enabling generative modeling of trees based on the reliable L-systems equation were utilized. By simulating tree growth, different stressors and extreme environmental conditions were applied at various stages throughout the trees’ lifetimes.









2.0_phototropism
3.0_phototropism2








4.0_gravitropism




TREE GROWTH SIMULATION
TREE ADAPTIONS
Key correlations tested included the relationship between tree growth proximity to a light source, known as phototropism, and the relationship between tree growth directionality and gravity, known as gravitropism. These results were compared to a control simulation where no environmental factors were altered throughout the timeline. The findings were visually evident, demonstrating a strong positive correlation between light, gravity, and tree growth.
The resulting tree architectures were immensely diverse, each telling a unique story about its environment and resilience. This study highlights the intricate and adaptive nature of trees, showcasing their ability to thrive under varying environmental conditions.




5.0_phototropism2 6.0_phototropism2
























LONDON PLANE

TREE SHAPING SIMULATION















THE DECAY
This section examines the controlled decomposition of wood materials to develop sustainable structures. Using programmable wood decay through surface milling patterns and bioinformatics, the research aims to manage decay rates effectively. This approach enhances structural longevity and ecological integration, providing insights into the role of decomposition in sustainable design.


MODELING BIO-INFORMED MOLECULES...
ENVIRONMENTALFACTORS
Highly opportunistic and less resistant
stage i
FUNGALGROWTH
carbonhydrateweightmolecularmasshyphaldensitymoisture

Latent fungal inhabitants like primary saprophytes are triggered to grow and expand
Moisture content falls
Ascomycotan fungi feed on low-molecular weight carbohydrates
stage ii
Basidiomycota
Contain both white and brown rot species
Highly competitive and strong decay abilities

stage iii
Soft rot fungus
Percentage of lignin increases
Wood becomes humid and nutrient rich
Highly competitive and specialised


WOODDEOMPOSITION





The enzymes and protein folding becomes more complex as the available molecules in the wood becomes more complex
Translate this to a language of patterns engraved on the wood that portrays what is happening at a molecular level
DESIGNING WITH MYCELIUM

TREE ECOLOGY AND THEIR RELATIONSHIP WITH FUNGI.
In nature it is a given that most organisms do not exist in isolation and rather in mutualistic and symbiotic relationships with other organisms that increase their fitness and survival. For example, mycorrhizal fungal networks that intertwine with tree roots, exchange critical nutrients with the tree and are believed to allow for the transfer of nutrients between different trees (Suzanne Simard).
Out of all the organisms that are saproxylic, fungi play the most critical role in decomposing wood by proudcing extracellular enzymes and transfering these nutrients through hyphal networks known as mycelium.
A particular group of decomposer fungi known as brown-rot fungus only degrade hemicellulose and cellulose due to their enzymic units and so do not decompose lignin. This is particularly evident in older trees that are missing heartwood, which is now seen as natural process of ageing. Fungal species that live symbiotically with these trees only decompose the centre wood which possesses no function in the living tree. In esssence, the fungi release carbon-containing molecules trapped in the non-living part of the tree for the living part of the tree to use in metabolism and survival. This process is prevalent in most oak tree life cycles, therefore brown-rot fungal species commonly associated with the oak tree were chosen for further mycelium composite studies.
FUNCTION IS THE SUM OF ITS PARTS.
If we want to simulate the what is happening in the microhabitats and life cycle of trees we need organisms that decay wood to fulfil the important function that decay serves in releasing carbon and carbon sequestration in forest ecosystems.






MYCO TREE CIRCULAR CONSTRUCTION
MYCELIUM FURNITURE PHIL ROSS
DESIGNING WITH MYCELIUM

PRECEDENTS
Pulp Faction by bioDigital matter
Woodchips + paper pulp + kaolin clay
Byssomerulius corium + Gloeophyllum
Vormvrij Lutum v4






paper + wheat bran
(10% of dry weight content)

Custom extruder
Tilted Arch by Modanloo
Shredded
Pleurotus ostreatus
Shredded paper + wheat bran
Pleurotus ostreatus (10% of dry weight content)
Custom extruder



Multi-Material Fabrication
odanloo et al., 2021
t (10%






Paper pulp + secondary material:
sand (0.02–0.05 mm) and gravel (4–8 mm)
Ganoderma Lucidum
3D-Printing of Biomass-Fungi Composite Material
Ecovative GIY mixture
Delta WASP 2040


MyCera
Sawdust (<2 mm) + bleached and unbleached cellulose
Pleurotus ostreatus
Delta WASP 40100
EXTRUSION WITH MYCELIUM


FUNGI INOCULUM
EXTRUSION TEST
Pleurotus ostreatus is a ligninolytic fungi (white rot) that has the enzymatic ability to decompose all three principal polymer classes found in wood:


DECAY

Cellulose
Hemicellulose
Lignin

SPENT COFFEE GROUNDS
- 39% hemicellulose
17% proteins
2% fat
BAMBOO FIBER - 24% lignin
1.3% ashes - 34.5% cellulose - 26% lignin

2.5% hemicellulose








Clay Wheat bran (additive)
Psyllium husk (gelling agent)
FUNGI INOCULUM
EXTRUSION TEST fungi inoculum extrusion test
mat A mat A gelling agent shrinkageextrudabilityholding shape
B
psyllium husk
C
psyllium husk
mat D
psyllium husk
wheat bran
bamboo fibre
wheat bran
sawdust
gelatin
mat
mat









data analysed through RStudio and Dada2





Abundance of fungal species in a healthy oak tree







Solicoccozyma aeria
Coprinellus micaceus
Lyomyces erasti
rimosoides fungi
Further
Studies
the different functions of groups of organisms critical to the oak what environmental parameters will affect this where to place the substructure containing mycelium








abundance of organisms
functional diversity
diversity of organisms
“Mycelium enhances tensile strength along the extrusion axis by 66.62% and the connection between the single layers by 32.34%. ” Jauk J. et al., 2022.




Substructure of clay-mycelium can bind mycelium fabric
“The mycelial connections were able to structurally connect bar and node elements” Jauk J. et al., 2022.
3D print clay-mycelium around branches
3D PRINT & SLIP CAST
PROTOCOL OVERVIEW
1.

2.
3.
4.







3D PRINT & SLIP CAST
TESTING VARIOUS SURFACES
FOR HIGHEST VITALITY


large surface area


small surface area volume













































Slip
2/3 clay






1/3 substrate (oak sawdust:coffee:wheat) bran
Fistulina hepatica (Beefsteak mushroom)


Laetiporus (Chicken of the woods)
Laetiporus (Chicken of the woods) Fistulina hepatica (Beefsteak mushroom)




CULTIVATION & GROWTH EXPERIMENT






























Fistulina hepatica (Beefsteak mushroom)
Laetiporus (Chicken of the woods)


2/3 clay 1/3 growth medium

























1:1:1




























Fistulina hepatica (Beefsteak mushroom)







Laetiporus (Chicken of the woods)
CULTIVATION








































Laetiporus appears more resilient than Fistulina hepatica to contamination as can be seen in both the generic growth medium and the clay:substrate plates.
The co-culture of both Laetiporus and Fistulina hepatica appears more hydrophobic than the single culture plates.






Contamination is apparent throughout many of the plates not shown here which is common when working with mycelium. More sterilisation is required during the process and/or perhaps looking to use a more resilient species of wood-decay fungi. No mycelium growth was observed by either fungal species in the bamboo
The clay slip applied to the prints were contaminated in the process as can be seen here from the majority coverage of the surface with organisms that resemble Trichoderma harzianum and Neurospora crassa in colour.



































































































THE MICROBIOIME OF A WOODLAND FOREST

THE MICROBIOIME OF A WOODLAND THROUGH DIFFERENT STAGES OF SUCCESSION
WOODLAND FOREST ANALYZED SUCCESSION


THE DENSITY AND DIVERSITY OF MICROORGANISMS ARE IN CONSTANT FLUX

REMAZOL BRILLIANT BLUE
AREA + EXTENSION RATE
PROTOCOL
PRE-INOCULATION + ASSEMBLY HISTORY






IMAGE ANALYSIS
REMAZOL BLUE






GOLDEN
GOLDEN
CHESTNUT
CHESTNUT
LIONS
TURKEY





CHICKEN


CHICKEN CHICKEN
GOLDEN
TURKEY
TURKEY
IMAGE ANALYSIS
ASSEMBLY HISTORY

IMAGE ANALYSIS
ASSEMBLY HISTORY

PRE-INOCULATION SPECIES








TEMPERATURE & GROWTH
RESPONSE: EXTENSION
Trametes versicolor
Cordyceps militaris
Laetiporus sulphureus
Pleurotus citrinopileatus
Hericium erinaceus
Pholiota adiposa






TEMPERATURE
& GROWTH
RESPONSE: AREA

Trametes versicolor
Cordyceps militaris
Laetiporus sulphureus
Pleurotus citrinopileatus
Hericium erinaceus
Pholiota adiposa
CORDYCEPS


CHICKEN




GOLDEN
CHESTNUT
LIONS
TURKEY
TEMPERATURE & GROWTH
RESPONSE: AREA
ANALYSIS OF VARIANCE

Trametes versicolor
Laetiporus sulphureus
Pleurotus ostreatus
Pleurotus citrinopileatus
Hericium






Pholiota a iposa


SURFACE PATTERNING FOR CONTROLLED DECAY





DECODING CHAOS:
SINGLE VARIABLES IN COMPLEX AGGREGATES
In bio-integrated design, the challenge lies in using natural materials like tree branches while respecting their inherent patterns. This involves creating algorithms that guide the assembly of irregular natural shapes into functional and aesthetically pleasing designs.
To achieve this, advanced computational techniques such as parametric modeling and machine learning are used to analyze and predict interactions between natural shapes. These methods help balance the variability of natural forms with the need for structural stability and functionality.
The goal is to develop patterns that align with natural growth processes, maintaining structural integrity while respecting ecological ethics. This approach requires a shift from controlling nature to collaborating with it, creating structures that adapt to and support their environment.
Future directions involve deeper research into natural adaptation mechanisms and refining computational tools to better integrate these processes. The aim is to design in harmony with nature, creating sustainable and adaptable structures that enhance the world around us.
PRECEDENTS OVERVIEW
MATERIAL SOURCE
multi-species/random tree species
GEOMETRY
GEOMETRY ANALYSIS
DIGITAL INVENTORY sorting
bifurcation multi-nodal
DESIGN SOLUTION
OPTIMIZATION
DESIGN TOPOLOGY
best matching score
folllows connection rules
highest tness calculation
Amtsberg, F., Huang, Y., Marshall, D. J. M., Moreno, K., & Mueller, C. (n.d.). Structural Up-cycling: Matching Digital and Natural Geometry.
matching algorithm
STRUCTURAL ANALYSIS
matching cost
connectivity rules
tness function
generative GA
Zirek, S. (2023). Bottom-up generative up-cycling: A part based design study with genetic algorithms. Results in Engineering, 18, 101099. https://doi.org/10.1016/j. rineng.2023.101099
Kröhnert, D. (n.d.). Conceptual Joining: Branch Formations. Retrieved May 27, 2023, from https:// www.academia.edu/37719834/Conceptual_ Joining_Branch_Formations
reciprocal aggregation
OVERVIEW
design-to-fabrication workflow


SOURCING


RE-ARRANGEMENT




















3D scanning is used for obtaining, processing, and analyzing the irregular geometries of locally-sourced tree wood. Once scanned, 3D point clouds of the wood pieces are cleaned and converted into useable meshes within a computer modeling environment. Important geometric data can be easily extracted from these meshes such as centerlines, branching angles, average circumference, curvature, and dimensions. This data is then stored alongside its mesh within a digital database for future reference. The significance of 3D scanning is that it enables the direct integration of construction material into a design, completely avoiding financial, environmental, and time costs required for the use of standardized materials in construction.
tree fork analysis & categorization










GEOMETRY ANALYSIS
DEAD TREE M

GEOMETRY ANALYSIS
Desai, I. (n.d.). Designing structures with tree forks: Mechanical characterization and generalized computational design approach.
SINGLE TREE COMPONENT
INDIVIDUAL BRANCH ANALYSIS

The diagram to the left illustrates how part geometry can be created using engaging mathematical applications. Leonardo da Vinci’s rule has been applied to model tree geometries based on a specific and consistent mathematical ratio of branching angles, as well as the lengths and widths of the branches. This method allows for fairly accurate calculations of a hypothetical tree’s dimensions, provided at least two variables are known.
WHOLE TREE ARCHITECTURE
age: girth: 80-90 cm height: 9-12 m width: 4-6 m
MATERIAL SOURCING
MULTI-TREE SOURCING












Wood material is collected from the forest floor. The resulting inventory from this methodology will be a randomized collection of tree branches sourced from various types of trees. This means the geometries of each tree part will be more unpredictable. Wood material is collected from the forest floor. The resulting inventory from this methodology will be a randomized collection of tree branches sourced from various types of trees. This means the geometries of each tree part will be more unpredictable.
SINGLE-TREE SOURCING





Wood material collected from a single tree or species of tree will be easier to catalogue and the geometry components will have higher accuracies of representation. The downside to this method is that it would require specific tree species to exist on site and/or the cutting down of a tree for pieces.
TREE PART GEOMETRY

There are various methods in which branch geometry can be represented in a 3D modeling environmentor for simplified aggregations and tests. Three mehtod are of tree part geometry creation/representation have been explored in the reciprocal aggregation experiemnts, The three methods are as follows:
1. Parts modeled after actual parts from tree
2. Proto-parts generated from standardized space-filling geometries (proxies)
3. Procedurally generated parts based on tree morphology data
another approach to generate these organic geometries is to use pieces that represent tree section through generative modeling and assumes these pieces approximate standardized averages of the branch units

This figure represents the first method, where parts were directly modeled from the cut sections if the tree that were used in some of the first scaffold jointing experiments.
method 2: proto part- using space filling geo to represent a standardized version of the tree geo
TREE PART GEOMETRY
DEAD TREE M AT ERIA L
METHOD 1: PROXIES
TREE PART GEOMETRY
forming variations of tree branch geometries in grasshopper rhino using standard lines starting at the centroid of the hexagonal prism volume and connecting to points multi-piped to form a tree branch geometry.
Proxy Geometry: This method involves using simplified versions of complex geometries as stand-ins during the initial dealing with intricate organic shapes because they allow for faster computation and easier manipulation while retaining context of Wasp, proxy geometries enable the exploration of large-scale aggregations without the computational overhead approach to study spatial arrangements and structural configurations before committing to the detailed final design.

One approach to generate geometry pieces method that assumes an approximate
rdized 3D geometries such as a hexagonal prism. The process starts by creating a network of points from the centers of selected faces extracted from the hexagonal prism. These lines are then
initial stages of design and analysis. Proxy geometries are especially useful when retaining the essential form and functionality of the original geometry. In the overhead associated with more complex models. They serve as a practical

ces that represent tree sections for aggregation studies is through a generative standardized average of branch units.
METHOD 2:: PROTO - PARTS











ATTRIBUTING LOGICALLY ASSIGNED, STANDARDIZED GEOMETRIES AS PROTO-PARTS:
In this strategy, standardized geometries are designated as proto-parts, which are basic building blocks used to construct more complex forms. These proto-parts are predefined with specific attributes and rules that dictate how they connect and interact with each other. In Wasp, assigning logical attributes to these standardized geometries allows for the orderly aggregation of these parts, creating a structured yet seemingly random assembly that mimics the chaotic yet ordered nature of natural materials. This method is particularly effective for scaling models to larger sizes while ensuring that the overall design adheres to a predetermined set of rules or patterns, facilitating both creativity and control.

PHYSICAL BRANCHES

D IGITALIZED

ASSIGNING BRANCHES
DESIGN

IGIT ALIZED
DA TA BASE

SYSTEMS LOGIC
CONNECTION RULES
all connections

self connections




















In the context of using WASP for Grasshopper, rule generation plays a pivotal role in directing the patterns and forms that result from the aggregation of components. Rules in WASP are essentially sets of constraints and directives that determine how individual elements connect and interact with each other within a design. These rules are typically defined based on the geometric and topological properties of the components, such as connection points, allowable angles of connection, and the types of connections (e.g., end-to-end, side-to-side). A simple rule might specify that certain types of pieces should only connect at specific angles or must align with certain directional vectors. By establishing these kinds of rules, designers can influence the structural integrity and visual pattern of the aggregation, ensuring that the assembly behaves in predictable and desirable ways.
Moreover, the patterning of aggregations in WASP can be affected by how these rules are applied in sequence or hierarchically. For example, a primary rule could dictate the overall branching structure of an aggregation, while secondary rules might fine-tune the aesthetics or functional aspects, such as varying the density or orientation of connections to create visual rhythms or to respond to environmental factors like light and shadow. This hierarchical application of rules allows for the development of complex patterns that emerge organically from simple, local interactions between parts. The capability to iterate and adjust these rules dynamically in the digital modeling environment enables designers to explore a wide range of design possibilities, facilitating a design process that is both highly controlled and creatively open-ended, ultimately leading to intricate and tailored patterns in the final architectural structure.


The initial aim of this experiment was to avoid collisions while adding part number and quantities
SORTING
In our project, we use the positioning of various starting pieces as a foundational rule in our branch aggregation process, which is a powerful method for guiding the overall form and functionality of our design. By strategically selecting and placing these initial elements, we can effectively direct the subsequent aggregation, ensuring that the structure evolves according to our aesthetic and structural objectives. The choice of starting pieces is based on their geometric properties, structural capabilities, or their symbolic meaning within the overall context of the music festival. For example, we position larger, more robust pieces in areas requiring greater structural integrity, such as the base or main audience areas of the stage. Alternatively, we use visually striking or uniquely shaped pieces as focal points around which the rest of the structure organically develops.





















Positioning these starting pieces also plays a crucial role in influencing the design’s development trajectory. By varying the orientation, height, and spacing of these initial elements, we control the flow and density of the aggregation, creating dynamic spaces and pathways within the structure. This method allows for a controlled yet flexible design process, where adjustments can be made in real-time based on the assembly’s evolving form. Moreover, incorporating principles such as symmetry or radial patterns in the placement of starting pieces introduces an underlying order, enhancing the aesthetic coherence of the final structure. This approach not only facilitates a logical build-up from the bottom up but also ensures that the resulting architecture is both functionally effective and visually compelling.



SCAFFOLD DESIGN
GRADIENT SUBTRACTION BASED ON MESH CONSTRAINT















Mesh constraints are a fundamental tool in computational design, used extensively to control and refine the geometrical outcomes of architectural models. These constraints help define the shape, size, and curvature of mesh surfaces, allowing designers to achieve specific aesthetic or functional characteristics within a design. For instance, in architectural projects using tools like Grasshopper and WASP, mesh constraints can be applied to ensure that the surfaces do not deviate beyond certain curvature limits, maintaining structural integrity or fitting within predefined spatial boundaries. They can also be used to control mesh density, which is crucial for both the physical realization of the model and its visual appearance, ensuring that the mesh is neither too heavy for practical implementation nor too sparse to achieve desired visual effects.
Furthermore, mesh constraints facilitate the integration of engineering requirements directly into the design process. By imposing limits on aspects such as mesh tension or compression, designers can preemptively address structural concerns, adapting the mesh to distribute forces efficiently across the structure. This integration of constraints not only optimizes material usage—making structures more sustainable and costeffective—but also enhances safety and durability. Additionally, in the context of dynamic or adaptive architectures, mesh constraints can be programmed to change over time or in response to external stimuli, such as environmental conditions or user interactions. This adaptability allows for the creation of responsive environments that can shift and evolve, providing tailored experiences and interactions that are not possible with more rigid design methodologies.
SPATIAL ELEMENTS:

SPATIAL ELEMENTS

SPATIAL ELEMENTS: BRANCHES


RULE GENERATION


horizontal cells
higher density




OPTIMIZATION
MATCHING ALGORITHMS




Iterative Closest Point
Hungarian Algorithm


OPTIMIZATION
GENETIC ALGORITHMS







OPTIMIZATION
RECIPROCAL AGGREGATIONS
Sorting can be a crucial design tool in the WASP approach to architecture, particularly when dealing with a large inventory of discrete elements such as wood pieces from felled or fallen trees. By categorizing these elements based on specific attributes—such as length, curvature, diameter, or even decay state—you can create a systematic method for selecting and aggregating components. This sorting process allows you to strategically deploy materials where they fit best, both structurally and aesthetically. For instance, sorting wood pieces by strength or flexibility could determine their use in structural versus decorative parts of your festival stage. Similarly, elements with more interesting textures or colors might be prioritized for visible areas to enhance the visual impact of the structure.
Beyond physical characteristics, sorting can also involve the digital tagging of each piece with data about its origin or potential load-bearing capabilities, which can be crucial for integrating with structural analysis tools. In the context of WASP, this means that each sorted category can be associated with specific aggregation rules and constraints that guide the automated assembly process. For example, heavier and more robust pieces might be automatically allocated to the base of the structure to ensure stability, while lighter pieces could be used higher up or in areas requiring less structural support. This method not only optimizes the material usage, making the construction process more efficient and sustainable, but also allows for a more creative exploration of form, as the sorting parameters can be adjusted to push the design in new and unexpected directions.







Displacement













Equivalent Stress











OPTIMIZATION
STRUCTURAL ANALYSIS
In this structural analysis experiment using Karamba3D, we assess a structure composed of 15 semi-randomly aggregated mesh elements representing tree branches. By converting these meshes into beam elements and subjecting them to simulated loads, we identify the weakest and strongest areas. The analysis focuses on displacements, stress distributions, and material utilization, visualized through color-coded diagrams. This iterative process helps optimize the structure by refining design elements like material properties and support configurations.
This experiment uses physics simulation software to analyze the stability of 3D models on a plane, which is crucial for architectural stability. By simulating gravitational interactions with platforms like Blender or Unity, architects can predict potential structural issues, enhance design efficiency, and improve safety in building projects before construction. This approach is an effective preliminary testing tool in architectural design.










OPTIMIZATION
EVOLUTIONARY ALGORITHMS
HTTPS://YOUTU.BE/VH5Z33BEURS

GENETIC OPTIMIZATION OF AGGREGATION
To achieve an aggregation with the least total volume, genetic optimization was employed using Galapagos within the Rhino/Grasshopper environment. The optimization process began by generating initial seed configurations for the WASP aggregation of branches. Each configuration was placed inside a bounding cube, and the volume of the aggregation was determined by calculating the difference between the cube’s volume and the volume occupied by the branches. Galapagos iteratively adjusted the parameters to minimize the total volume of the aggregation. This process involved filtering and sorting through datalists to identify and retain the configurations that met predefined standards of efficiency and compactness. By continuously refining the aggregation parameters, a solution was achieved that minimized volume while maintaining structural integrity and aesthetic appeal. This approach demonstrates the powerful synergy between computational tools and genetic algorithms in optimizing complex geometrical arrangements.


sourcing from one species
sorting through pieces is part of the design process and logic
PATTERN RECOGNITION
mesh constraints


xy plane constraint

connection angle
part-depeneden


connection rules








part geometry -depenedent transformations














FIELD-DRIVEN AGGREGATIONS
GRADIENTS OF CONSTRAINT
Field-driven aggregations in architectural design utilize spatial fields to guide the distribution and organization of structural elements. A field, in this context, is a spatially varying parameter that influences the behavior and placement of components within a design space. By defining fields based on various criteria such as stability, accessibility, light, ventilation, and aesthetic patterns, designers can create a gradient of control that seamlessly integrates multiple functional requirements. This gradient of control allows for smooth transitions and nuanced adaptations in response to different environmental and functional demands. Field-driven aggregation is crucial in bio-integrated design research because it enables the creation of structures that mimic natural forms and processes, promoting harmony between built environments and their biological contexts. By leveraging the principles of field-driven design, architects can develop innovative, sustainable, and adaptive spaces that respond dynamically to their surroundings, much like natural ecosystems.


Here is a sketch detailing the role of volume vs. surface fields in a field-driven aggregation for a collaborative lounging space made from found tree at or gently curved areas for group activities, represented by gradients or lines indicating field uence. The sketch includes clusters of branches forming communal spaces, clear pathways, seating areas, and denser areas for shade and partial privacy. Arrows and
SURFACE FIELD


VOLUMETRIC FIELD

COMBINED FIELDS APPLIED TO BRANCH AGGREGATION DENSITY
FIELDS & FORM
ARCHITECTURAL DESIGN USING
FUNCTIONAL GRADIENTS
In architectural design, the interplay of surfaces and volumes plays a critical role in shaping forms that meet functional requirements and aesthetic goals. Surfaces, whether horizontal, vertical, or undulating, guide the creation of spaces that promote specific activities such as lounging, climbing, or collaborative interactions. Volumes, on the other hand, define the spatial boundaries and influence the distribution and density of elements within a structure. Important considerations when designing with these elements include stability, ensuring the structure is secure and can support loads; accessibility, providing clear and navigable pathways; light and ventilation, allowing adequate natural light and airflow; privacy, creating secluded spaces for individual activities; aesthetics, achieving visual harmony and appeal; adaptability, allowing for modifications and reconfigurations; and integration with the surroundings, ensuring minimal environmental impact and contextual harmony. By carefully manipulating surface and volume fields, architects can generate complex, functional, and visually appealing temporary structures, such as those made from found tree branches, tailored to specific uses and environmental contexts.




















CLIMBING WALL



INTERACTIVE SPACE



LOUNGING SPACE



SURFACE FIELDS + ARCHITECTUREAL FORM

ranges of sound and lighting for various activities can be programmed and appllied within an aggregation field
various criteria of the space dictate various characteristics of the final aggregation using fields. In our explorations we examined the properties of density, porosity, opennes/enclosure, and orientation. Using a voxel field, we are able to map gradients of needs per allocated space and its activity

FIELDS + ENVIRONMENTAL DATA



Surface Fields for Environmental Response:
Surface fields are scalar or vector fields applied to surfaces that influence the aggregation of branches based on environmental factors. For example, a scalar field representing sunlight intensity across a building facade can guide branches to orient themselves to maximize shading in certain areas while allowing light penetration in others. This can create dynamic facades that respond to solar exposure, enhancing energy efficiency and occupant comfort. Similarly, a vector field representing wind direction can guide the branches to form wind-resistant patterns, reducing the impact of strong gusts and improving structural resilience.








ARCHITECTURAL CONSTRAINTS
PLANE CONSTRAINTS

Using various starting pieces and their positions as foundational rules in the aggregation process is an effective method for guiding the overall form and functionality of a design. By strategically selecting and placing these initial elements based on geometric properties, structural capabilities, or contextual significance, the subsequent aggregation can be directed to meet specific aesthetic and structural objectives. Larger, more robust pieces are positioned in areas requiring greater structural integrity, such as the base or primary support regions. Unique or distinctively shaped pieces can serve as focal points, around which the rest of the structure develops.

SUPPORT + PLANE CONSTRAINTS

The orientation, height, and spacing of these initial elements significantly influence the design’s development trajectory, controlling the flow and density of the aggregation and creating specific spaces and pathways. This method allows for a controlled yet flexible design process, enabling realtime adjustments based on the evolving form of the assembly. Incorporating principles such as symmetry or radial patterns in the placement of starting pieces can introduce underlying order, enhancing the structural and functional coherence of the final design.




MESH + PLANE CONSTRAINTS



ARCHITECTURAL CONSTRAINTS
MESH + VECTOR FIELDS

MESH CONSTRAINTS

SURFACE FIELD

combined mesh and surface field constraints to produce an aggregation of branches resembling a picnic area
MESH AND SURFACE FIELD CONSTRAINTS FOR BRANCH AGGREGATION
Using mesh constraints, branch placement is guided to ensure structural stability, mimicking forms like a vaulted ceiling to create strong, arch-like networks. The mesh provides a stable structural framework, ensuring even load distribution and overall coherence.
Surface fields, influenced by environmental factors such as sunlight and wind, further refine this placement. Sunlight fields drive branches to aggregate densely in shaded areas, enhancing thermal performance, while wind fields orient branches to form streamlined, wind-resistant patterns, improving structural resilience.
The integration of mesh and surface fields results in designs that are both robust and adaptive. The mesh provides the overall structure, while surface fields allow for localized adjustments in branch density and orientation to optimize environmental performance.
In pavilion structures, this approach shapes the overall form using the mesh while surface fields enhance shading and ventilation. For facades, the mesh defines the form and surface fields adjust branch density to balance light and shade. In interior spaces, the mesh outlines primary areas and surface fields create semitransparent partitions that allow light permeability while maintaining privacy.
This combined methodology ensures that branch-based architectural designs are not only innovative and visually appealing but also structurally sound and environmentally responsive.
RELATIONSHIP BETWEEN FIELDS & ARCHITECTURAL CRITERIA

COMBINED FIELDS & ARCHITECTURAL CRITERIA

BASED ON ENVIRONMENTAL DATA


CHAPTER
THE MAKING 05
In project Growth and Decay, the making of the tree structure focused on integrating conventional arborsculpture technique and the novelty of digital fabrication. As mentioned in introduction, tree shaping and grafting has long been a fascinating research for arborists and botanists. On the other hand, timber structure and cranftmanship has been one of the main architectural material throughout human history. Timber tectonics has progressed and evolved with contemporary fabrication technology greatly in the past twenty yeaars. There has been studies such as Baubotanik which explores the tectonics of tree inosculation with rigorouus experiments and data comparison. However, understanding the advantages of utilizing digital fabrication and environmental simulation in shaping tree spaces has yet to be explored. Hence, our research investigates into how efficiency can be improved in terms of material construction and how can space better adapt to the woodland habitat or even enhance the microhabitat.































TREE-TO-TRUSS







JOINERY STUDIES
Wood joinery has been a traditional art in Japan since the 12th Century. The traditional Japanese wood joinery notches slabs of timber, locking the grooves together into a steady structure, rather than depending on glue or other fasteners.

Jointing methods
Grafting methods

End-to-end
End-to-side
Japanese joinery I
Japanese
joinery
II
Cleft grafting Side grafting
Tongue grafting








The advance of 3D printing allow us to assembly wood pieces in a more customizable way. Using different materials such as steels, PLA, biomaterials, the material properties can be better designed to align with our needs.

Arup, 2014
Hybrid Carpentry, Magrisso S et al., 2019
JOINERY & GRAFTING


WOOD JOINTS IN CLASSICAL JAPANESE ARCHITECTURE.
traditional japanese joinery
Timber joinery is famously influenced by the Japanese joinery technique Kumiki, which can be dated back since the 7th century. Wood elements are interlocked together seamlessly by intricate tongue and groove-like joints. Using different angle rotation of cuttings and wedges, the wood can be locked without applying any glue or nails.
We started by categorizing the joinery from different parts of wood geometries into end to end, end to side, and side to side. The first test of tongue and groove joint, half-lap joint, cross-lap joint and dovetail joint indicated how the two parts of joinery requires more friction and locking from different angle to become fixated, which was later improved by adding a wedge as the locking piece to the joints. The early tests on standardized timber has further influenced the development of the fabricating process with our non-standardized branch geometries.






end to side side to side











rafting side grafting approach grafting
Comparing to the conventional tree grafting techniques to wood joinery techniques, two of them in fact are strikingly resembling. The common grafting techniques are tongue grafting, side grafting and approach grafting. Using Pruing knive, scissors the branches can be simply processed into desired shape. After applying grafting wax to prevent plant tissue from drying out before healing, the branches are assembled and wrapping with grafting tapes to hold shape.
Three types of trees were selected for the grafting experiments: london plane, crack willow and white willow. The trees were roughly a meter tall and stem width 0.5 centimeter.
After two months from the grafting, the tapes were removed and the trees were merged into one. The new shoots sprouting from the grafted scions indicates the vascular tissues have grown properly, the cut scion can rely on the nutrients and water provided by the stock trees.



side gra�





tongued approach gra�


TREE ARCHITECTURE
THROUGH JOINTS


BRANCHING





ENERGY SHADES
NETWORK
BONE & SKIN

CALIBRATION & FABRICATION
joint types
joints with irregular tree forks
fabrication methods























ROBOTIC MILLING
WORKFLOW OVERVIEW


ROBOTIC MILLING
In order to fabricate the aggregated complex structure with higher precision, a workflow was gradually developed to adapt with nonstandardized geometries. The branches were first clamped onto a holding piece created to fix and provide referencing origin. They were later scanned with Creaform to provide digital model for designing assemblage orientation and cutting geometries. Inital two tests were milled with CNC machine to create cross lap joint cuts. The branches we picked up from the fallen London Plane tree were around 5-7 centimeter width. The 3-axis milling indicated challenges in milling geometries with certain complexities and also difficulties in fabrication with high accuracy for branches to interlock. The other issue was being able to milling merely from one side, meaning the geometries has to be flipped or rotated to mill from different sides. This inevitably adds up to inaccuracy in the process.
The fabricated branches are designed to serve not only as scaffolds for tree growth, but also a structure with cavities to host wood-decay fungi. Therefore patterns are generated to create larger surface area and cavities for fungi to be inoculated. The first pattern milling test focused on creating various depth related to the intensity of light, to create shadowed spaces for fungi growth. The second test utilize robotic arm to create different pools and trenches throught out different sides of the branch.

branch diameter 4cm
branch length 30cm
CNC milling



branch diameter 4cm
branch length 30cm
KUKA KR6 milling












branch diameter 4-7cm
3d print rotational joint


MOVEABLE JOINT STUDIES

branch diameter 4-7cm
band saw machine pillar drill machine











THE END TO END JOINTS WERE EVENTUALLY SELECTED FOR FABRICATING THE TIMBER SCAFFOLD

THE ABOVE IMAGE SHOWS THE TYPE OF END-TO-END JOINT WE DECIDED TO USE. THIS JOINT IS SCALLED A CROSS-LAP JOINT AND PROVED TO BE THE MOST EFFECTIVE IN TERMS OF FABRICATION EASE AND STRENGTH
TREE SHAPING SCAFFOLD


The integration test explored different ways of shaping trees onto the aggregated scaffolds. London plane trees were tied onto the structure with linen thread and grafted. The first demonstrates how the trees can grow vertical until they reach the weak points of the

scaffolds. The two scaffolds were cut and assembled manually to understand the advantages of utilizing milling machines. Two first test demonstrates how the main loading structure of the scaffold can be strong enough to hold the trees as they grow. The second the structure and become part of the support structures.


The integration phase of the Growth and Decay project is where the magic happens, blending living, dead, and decaying tree components into a harmonious structure. With the help of advanced computational techniques and robotic fabrication, we’re building an installation that not only stands tall but also groves with the environment. This whimsical assembly enhances structural stability, aesthetic charm, and ecological sustainability— proving that when it comes to innovation and nature, we’re all bark and no bite!


VIDEO OVERVIEW
https://youtu.be/d7cXMgSLh_Y?si=Pgbiv4vcPzzWhbhN
SITE + DESIGN
SITE INTEGRATION
The integration of the site, Epping Forest, with the design of the Growth and Decay project is central to its success. Epping Forest, with its rich biodiversity and dynamic landscape, offers an ideal setting for the installation, enhancing the project’s ecological and aesthetic goals. The design leverages the natural contours and existing vegetation of the forest, ensuring minimal disruption to the environment. By incorporating locally-sourced tree materials, the project fosters a deep connection with the site, promoting sustainability and reducing the carbon footprint. The living components, such as the growing London Plane and willow trees, are chosen for their compatibility with the local ecosystem, ensuring they thrive and contribute to the forest’s health. This thoughtful integration creates a symbiotic relationship between the installation and its surroundings, allowing the structure to evolve naturally within the forest, enriching both the environment and the visitor experience.






WORKFLOW OVERVIEW


WOOD COLLECTION
Picture this: a group of determined designers, armed with chainsaws and wheelbarrows, navigating Epping Forest in search of felled wood. It was a sight to behold, part environmental mission, part comedy show. Despite the occasional stumble and the inevitable wheelbarrow mishap, we gathered the essential materials with a mix of dedication and hilarity, proving that even serious work can have its lighthearted moments.







The 3D laser scanning process accurately captured the details of the felled branches using high-resolution scanners. Each branch was scanned to create precise digital models, which were then cataloged into a digital inventory. Advanced software was employed to sort and analyze the data, enabling efficient organization of the branches. This digital inventory allowed for the application of computational algorithms to optimize their use in the design, ensuring that each branch’s unique geometry could be effectively integrated into the overall structure.


8-12cm
KUKA MILLING
SURFACE MILLING FOR CONTROLLED DECAY
Surface milling patterns were applied to the bark of found tree branches using a 6-axis robotic arm. The aim was to utilize these patterns, combined with extracted environmental data and bioinformatics, to effectively control the rate of wood decay.



MYCELIUM INTEGRATION
Integrating mycelium into our project involved incorporating fungal networks to enhance the ecological functionality and structural stability of the design. Mycelium, known for its ability to decompose organic matter and form symbiotic relationships with plants, was introduced to facilitate the controlled decay of wood components. This integration not only promoted nutrient cycling and soil health but also contributed to the overall resilience and sustainability of the installation by reinforcing the connections between living, dead, and decaying materials.


part 1 picnic


part 2 read


part 3 climb




FULL INTEGRATION
THE LIVING READ
DESIGN LOGIC
THE DEAD
THE DECAYING



CLIMB PICNIC









FINAL RENDERING
https://youtu.be/peSBAcT_UaQ?si=1QS4fgmVHXcW-rqx
FULL SEND FABRICATION
The in-progress fabricated prototype is designed to function as a fully interactive bench and covering. This primary structure acts as scaffolding, guiding the growth and shaping of young tree saplings over time. As the saplings mature, they will integrate with the prototype, creating a living, evolving installation that combines functionality with natural beauty. This prototype exemplifies our project’s vision of harmonizing built environments with organic growth processes.


IN CONCLUSION...
The Growth and Decay project showcases innovative research and practical application in bio-integrated design. By incorporating living, dead, and decaying tree components, it creates a dynamic, sustainable structure that harmonizes with its environment. Advanced computational algorithms and robotic fabrication demonstrate the potential of merging natural processes with modern technology for new architectural solutions.
This portfolio explores themes of resilience, adaptability, and sustainability across various contexts. From studying natural structures to integrating biohybrid systems, each project leverages nature’s wisdom to address environmental challenges and inspire future sustainable designs.
The interdisciplinary research, combining biology, engineering, and design, emphasizes a holistic approach to complex problems. The methodologies developed offer valuable insights for future bio-integrated design work. This portfolio exemplifies how integrating natural materials and advanced technologies can create sustainable, adaptive, and resilient structures, fostering harmony between human activities and the natural world.


BIBLIOGRAPHY










